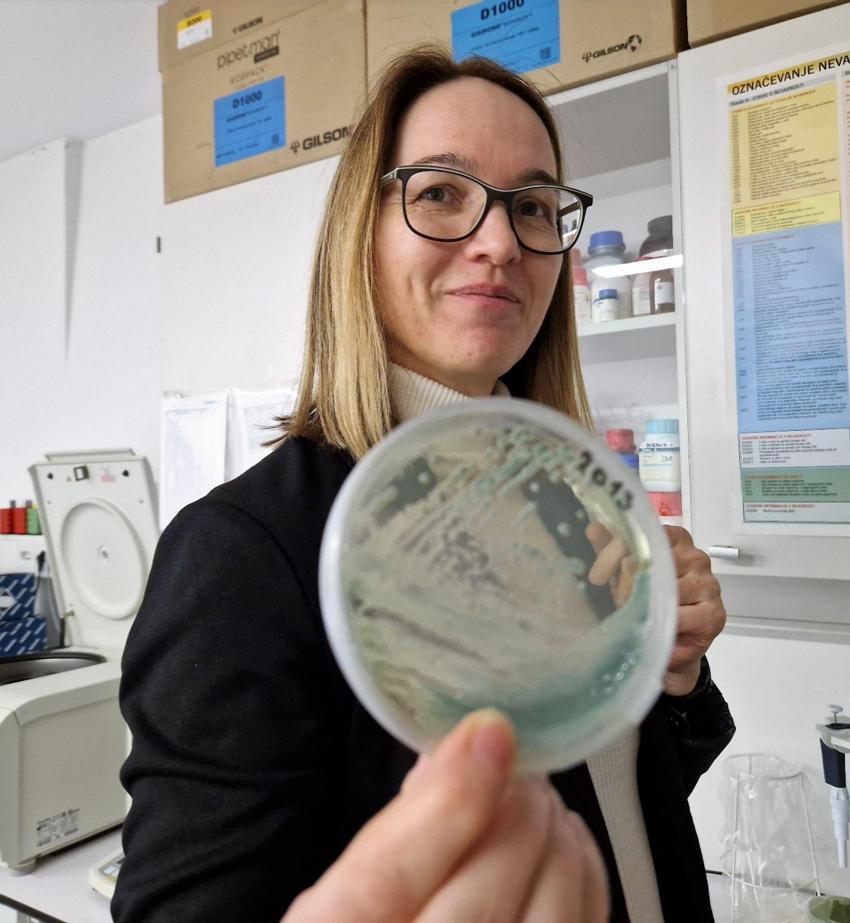

Director’s Editorial - Successes and Gratitude
Hasta La Vista
European Year of Youth
“Thanks note” from the Fund Operator - Mateusz Wiśniewski
“Thanks note” from the Fund Operator - Małgorzata Nowak
Shape Tomorrow Through Your Say
Celebrating innovation: let’s toast to your commitment - A Gratitude Note to all the members of the Regional Funds Family
EU funds: Ensuring compliance with fundamental rights
The best of
YES! The updated total numbers as of 31/12/2023
5 years of YES! Project
Social and financial inclusion: the experience of Microfinanza Srl within the YES! Project
Best Results of the YOUTHShare Project
YOUTHShare Project in a nutshell
The Best Results of the YOUTHShare Project
The Best Practices of the YOUTHShare Project
And one more exciting new by the YOUTHShare Project!
The
of
Uncorking Wine and Cider typicalities - What have we learnt from each other?
Nine international partners implemented a project to encourage social inclusion of children and young people with intellectual disabilities Track-IN
Groundwater – shared treasure and joint responsibility (EU-WATERRES)
“The best of” Project L.I.K.E - Life Investment is the Key to Employment
Reclaim Our Civil Space: results and impact
Diagnostics, Communication and Networking - The Best of the TBFVnet project
Regional Good Governance Public-Private Partnership Platform (R2G4P)
LEAD Project – Challenges. Results. Resources.
EURIBOR summary fact sheet
CCS4CEE
The Young Service Steward program in numbers
The Lost Millennials project
Inclusivity
Dear Friends,
I am looking at your shared results and I feel proud of all of you for the successes reached. I wanted to see those numbers (that are just summing up the efforts behind each Project) because I would like each of you to spend a few minutes to observe the great work that has been done over these years.
As this programming phase ended, even my role as Fund Director of the EEA & Norway Grants Regional Funds draws to a close: you know I always considered myself more a colleague, but I am filled with a profound sense of gratitude and pride for all that we have accomplished together, that is why I will always be grateful for this opportunity, I just hope I have been useful to you in some way.
Over the years, we have worked tirelessly to foster cooperation, development, and innovation across our countries, and the results speak for themselves.
One of our greatest successes has been our unwavering commitment to promoting sustainable development and addressing key challenges facing our communities: again, you can judge looking at the numbers presented here below. Through our various initiatives, you have made significant strides in areas such as environmental protection, social inclusion, economic growth, NEETs support. Whether it's supporting renewable energy projects, empowering marginalised groups, or fostering entrepreneurship, your efforts have had a tangible and lasting impact on the lives of countless individuals.
Furthermore, our collaborative approach has been instrumental in building strong partnerships and networks within our region and beyond, connecting people. By working closely with local governments, civil society organisations, schools and universities and other stakeholders, you have been able to leverage our resources and expertise to maximize our impact and reach. And what to say about the Regional Funds Online Mag? Together, we have created a platform for dialogue, exchange, and cooperation that will continue to drive positive change long into the future, I am sure.
As I reflect on my time into this Family that grown up, I am humbled by the dedication and passion of all those who have been part of this journey. From our staff and partners to the communities we serve, each and every one of you has played a vital role in this success. Your hard work, creativity, and resilience have been the driving force behind our achievements, and I am deeply grateful for your unwavering support.
We don't know what the future holds for us, but I am filled with optimism and confidence in the continued success of the EEA & Norway Grants Regional Funds’ impacts on the ground. While our work is far from over, I am certain that with your continued commitment and collaboration, you will overcome any challenges that lie ahead and continue to make a positive difference in the lives of millions.
In closing, I would like to express my heartfelt thanks to each and every one of you for your dedication, passion, and unwavering commitment to our shared mission. It has been an honor and a privilege to be not only your Fund Director, but especially your Friend, and I look forward to seeing the incredible impact that we will continue to make in the years to come, one way or another.
Last but not the least, a big thank also goes to all the colleagues who read, from Poland to Italy and passing through Brussels, where it all began.
Gian Luca Bombarda The Fund Director





THANK YOU for your commitment, for your perseverance (and, sometimes, patience ! ).






“Goodbye’s too good a word, so I’ll just say fare thee well.”
Bob DylanAnd so, it comes to this. As it does with most earthly things. For every beginning there has to be an end. Relationships, formed in hope and excitement have their own natural course to run. As Buddha says, “Nothing lasts forever, except change.”
Goodbyes are rarely happy events or occasions. Witness any departures terminal in airports that are transformed into tear-filled theatres of sadness; a famine of words, unspoken communications and taut embraces contribute to a crescendo of painful silence. We have all been actors in, or witness to, such scenarios. I wrote the below piece many years ago.
‘There were 32 people waving them off in the departure lounge at Dublin airport on that day in July 1977. As they moved slowly towards the departure gates and airside, he remembers their movements accompanied by a diminishing series of backward glances, the distance between them and the waving crowd lengthening, blurring the image, as if in soft focus. His memory’s misty lens has maintained a picture of the cover of the Sergeant Peppers LP. This was the first of many farewell scenes that would pepper their lives over the next 40 years. And Byron’s words echoed throughout:
‘All farewells should be sudden,’ compounded by the Bard’s ‘Do not tarry upon your goodbye.’
In the life of the EEA and Norway Grants partnership you have now reached a critical phase. A long-heralded parting of the ways. Will this be a culmination or a mutation? Only time can reveal its secrets.
For now, with an overhanging sense of ‘moving on,’ of ‘the end of the affair, ‘there will be the inevitable stock-taking, analysis, and lessons learned, peppered with a lexicon of ‘what if’ and ‘if only.’ There is the temptation, in the prevailing mood, to be hastened into erroneous evaluations and expectations. However blunted emotions may be, please be aware of what you have been part of, what you have contributed towards, what you have done. The collective work, the selfless investment of time and energy, the summation of your efforts in diverse sectors, with multiple communities, across borders has brought real change to peoples lives and livelihoods. There have also been many intangible, invisible benefits. You have been responsible for the creation of space, the growth of confidence, the gestation of hope. You have created a vast panorama of possibilities.
Your achievements, and there have been many, have laid foundations for the future. Then there are those that continue to be work-in-progress projects, some of which - generated and
nurtured by you - will now move along on their own momentum, mature, discover their own confidence; others will need a constant stoking of the furnace to keep the fires burning, while others might need to be shepherded to new fields.
Whatever future unfolds, you will have left behind a lasting legacy and bequeathed so many with an inheritance that offers more positive horizons.
And now, like parents preparing their children for lives beyond their care and tutelage, they often forget to prepare themselves for the voids in their new life. Such is life, conforming to chronology.
Your projects, your work has defied monumental challenges over the past four years, against and through backgrounds of Covid; wars in Ukraine and the Middle East; energy crise; stratospheric rises in the cost of living; the tilting to the right in policies of immigration; efforts at silencing independent media and the growth of disinformation and misinformation; the restrictions of space and movement of civil society; the rise of populism. Yet, you are still there and so are all the people you have helped, defiant and resilient.
I am proud, humble and grateful to have been a small cog in the relentless wheeling forward of your initiatives and projects. Mine has been that of a bit player, an extra called intermittently to the stage. This monthly foreword/preface enjoys incongruous
positioning in the front pages of the following anthology of actions and activities. But I am delighted to be part of that, by association. And then there is Gian Luca, the never invisible and often audible Magister Ludi, the patron of your works, advisor, confessor, motivator infusing your work with the oxygen of visibility. None of this would be possible without the invaluable inputs of Malgorzata and her support, along with Mateusz and Francesca. Through their efforts and the rest of the players in this international team you have evolved into a transnational Family with a joint heart and soul.
Back in 2020, I wrote the following paragraphs in a longer piece about the pandemic. Almost four years later I think it has even more resonance and relevance now.
‘A lot of life’s certainties and assumptions have been eroded, and it may be time now to press the reset button on erstwhile truths and convictions. Coronavirus has imbued an awareness of how little we know, how little we really control in our lives, and how easy it is to lose sight of what really is important. The staggering speed with which the virus has spread makes it impossible for any rational person not to understand the reality of human interdependence.
This experience teaches us that, as humans, we can only survive in interdependence. The borders and divisions we have constructed to mark out our own territories - what we own, what we defend - are exposed, even as we
seek to repair the problems by closing those very borders.
The ordinary and mundane have become difficult and dangerous. The football pitch, the cinema, the church the office, public transport – the spaces in which we mark and measure out our lives – are now potential danger areas.
Even after the virus is mitigated, its aftershocks and the new constraints it imposes will define what we do, how we work, how we travel and interact, how we socialise for the next decade. As we all embark on a restoration project, to pick up again the pieces scattered by the virus, we need to assess what we have learned, what to take with us, what to leave behind. This will be crucial as we review our work practices, principles and desired outcomes. There is currently a momentous shift from competition to cooperation, from individualism to group endeavour and from privatised to public and state means of working together. This is not a bad thing.
The long, reflective, meditative period, caused by the physical incarcerations, may be soon over, and it will be time to harvest the wealth of ideas and thoughts. The magazine offers a wonderful treasure chest, a clearing house, for the exchange and hopeful enactment of some of those ideas. Your experiences of the effects of the virus on your work will help bring that work into sharper focus, underlining its possibilities and potentialities. These shared experiences and thoughts/ideas need wider amplification via the magazine’s expansive outreach. It, in turn, can harvest and reflect these ideas, and can offer an engine room for
the driving principles that should govern your work: Interdependence, Rationalisation, Relevance.’
I leave you with the words of the American writer — William Arthur Ward, which could serve as your epitaph.
“Do more than belong: participate. Do more than care: help.
Do more than believe: practice. Do more than be fair: be kind.
Do more than forgive: forget. Do more than dream: work.”
Hasta la vista Thomas Mc Grath Our Irish Journalist

1. The main results of the European Year of Youth: key achievements/outcomes, any notable successes, milestones, or impactful initiatives

The European Year of Youth 2022 was a collective achievement. It mobilised the European Union institutions, Member States’ public authorities at different levels and youth stakeholders to seek new and effective ways to engage, connect and empower young people. The Year brought the EU, and the opportunities it creates, closer to young people.
More than 2,700 different stakeholders contributed to the objectives of the Year by organising more than 13,000 activities in 67 countries. The Regional Funds Online magazine and the Fund for Youth Employment were among them!
The Year included new initiatives inviting young people to speak up on what is important to them: policy dialogues between young people and Commissioners, Voice your vision platform, Youth Talks. The Commission launched youth networks such as the Bioeconomy Youth Ambassadors network, the Network of Young European Ambassadors to promote Holocaust remembrance, the Horizon Europe Young Observers, where the Commission invited over 127 Master-level students to attend and learn how EU research and innovation project proposals are evaluated and selected by Europe’s top scientists.
In the context of the European Year of Youth, the Commission launched initiatives, such as ALMA, an active inclusion scheme for disadvantaged young people, new European strategy for a better internet for kids (BIK+), the Green Track campaign and published new policy guidelines relevant for young people, for example the Council Recommendation on the mobility of young volunteers and the Council Recommendation on learning for environmental sustainability.
There are many more note-worthy achievements at European, national, regional and local level. I invite your readers to discover them in this report and in the

2. The EC perspective on how to sustain and further enhance the involvement of young people beyond the European Year of Youth, ensuring that young voices continue to be heard in policy-making processes.
The European Commission is committed to further delivering on young people’s expectations. On 10 January 2024 the Commission adopted a strategic document, which outlines 60 actions, which will give young people a greater say in EU policymaking and deepen the youth dimension in a range of EU policies.
We will build on the many existing initiatives and instruments, which are functioning well and are appreciated by young people, for example the EU Youth Dialogue and the European Youth Portal, and develop them further. We will also launch new actions, which were piloted in the Year of Youth (policy dialogues with Commissioners, EU youth stakeholders’ platform and European Commission Youth Network of youth correspondents).
The big novelty is the introduction of a youth check in the Commission to ensure that the effects of EU policies on youth are systematically taken into account when designing policies. The youth check will be implemented by making full use of the potential of the Better Regulation framework and consultation tools. It was young people, who launched the idea of a youth check. We listened to them. This is a concrete example that it is important to speak up. It is how you can influence the world around you.

We have already launched the reflection process and setup of the new actions, mentioned above. We are piloting the youth check applying it to a planned Communication on a Blueprint towards a European degree. We will continue to engage with young people and provide opportunities for them to voice their vision in shaping Europe. This is the aim of the 2024 European Youth Week, which will take place from 12 to 19 April. Just two months ahead of the European elections scheduled to be held on 6 to 9 June 2024, this is an occasion to celebrate and promote among young people democratic participation and active citizenship.
Biliana Sirakova DG EAC
Dozens of initiatives, hundreds of stories, thousands of pages of text – this is the result of the efforts of projects implemented under the EEA and Norway Grants’ Regional Funds in recent years. I have had the pleasure of being part of this. Working in the communications department on the Fund Operator's side, I had the unique opportunity to meet interesting, hard-working people while advising on implementing communication plans and developing information materials. Over the years, I observed how much work communication managers put into properly promoting the activities of their initiatives. Year after year, I noticed progress – the amount of content increased, new formats were proposed, and the materials became more and more attractive, also visually. Eventually, it was no longer reports, articles and infographics that were being created but entire documentaries. We all had one goal – to tell the stories of the people on both sides of all these projects. Today, I can proudly say that we have succeeded. Because it is the human being that is always most important. And I thank you all for that.
Mateusz Wiśniewski Lead Communication Consultant Regional Funds Online Mag Editorial TeamAs we reach the conclusion of our collaborative Regional Funds journey, I wanted to take a moment to express my deepest gratitude to all the Project Partners for their unwavering dedication over the past seven years. Together, we've embarked on a remarkable endeavour, we’ve tried new approaches, tested new solutions, failed and succeeded, and learned from our experiences. It's truly been an honour to work alongside such talented and dedicated individuals.
Reflecting on our journey together, I am filled with pride and appreciation for all that we have accomplished. From the initial ideas to the countless milestones our projects have achieved, each step of the way has been marked by your expertise, passion, and commitment. Your contributions have not only shaped the success of the Regional Funds but have also left a lasting impact on your teams and the communities you serve. Your insights, feedback, and collaborative spirit have been instrumental in overcoming challenges and driving innovation, and for that, I, and the whole Fund Operator’s team, are immensely grateful.
As we part ways, I want to express my heartfelt thanks for your partnership, professionalism, and commitment throughout this journey. I will cherish all our meetings, discussions and brainstorming, all your hard work and dedication which resulted in impactful projects across Europe.
While this chapter may be coming to a close, I am confident that the relationships we've built and the lessons we've learned will continue to inspire and guide us in our future endeavours. I look forward to the opportunity to collaborate again in the future and wish you all the best in your upcoming undertakings.
Thank you once again for being an integral part of the Regional Funds family. It has been an honour and a privilege to work with you.
Warm regards,
Małgorzata Nowak Fund Manager
Although I am a recent member of the Fund Operator team, I had the chance to witness and value your motivation, commitment, and eagerness to address the current societal challenges through the implementation of your projects as concrete realisation of your ideas. As recipients of the EEA Norway Regional Funds Grants, you had the key to not only opportunities but also to contribute, by making available your studies, your recommendations, your products, and tools, influencing the policies that directly impact your and our lives.
We all know, however, that the key and the turning twofold point remains to find a space for discussions, for disseminating results, analysis and to establish a dialogue with relevant decision makers. This task is quite challenging as most of the time rely on the willingness, on the vision of the parties involved and how much mindful their work is conceived.
This is both my personal consideration and the conclusion of exchanges held with some of you over the recent past. This is the reality, or better to say a part of the reality, but it should not be forgotten that we all - young people and a bit elder - are not just beneficiaries but architects of change.
Your projects have been conceived in this perspective, but how can you, can we continue to make these efforts sustainable, impactful? I would say the first step is exercising active citizenship and proactively engaging and working with your community key actors. Another opportunity that I would like to share with you is offered by the "Have Your Say" portal emerging as a vital tool in amplifying your voice. It is an online space designed for you to voice your opinions, concerns, and aspirations directly to the European institutions – the main policy and decision makers of our common European House (https://have-yoursay.ec.europa.eu ). This platform is not just a tool; it is a bridge between your ideas and the policymakers who can turn them into reality. Through "Have Your Say," you have the chance to contribute to the discussions on policies that matter most to you and to directly engage with issues close to your heart. Be it climate change, education, employment, or social justice, employment, this platform ensures your perspectives are not just heard but considered in the decision-making process.
"Have Your Say" is not just an invitation; it is an opportunity to actively shape policies, it is the space, platform most of you, us were looking for. By staying informed, participating in discussions, and contributing your thoughts, you break down barriers and become an integral part of the democratic dialogue and participatory policy making process. Shape Tomorrow through your Say!
To not forget, there is also another powerful tool in our hands: the elections. It's not just about voting; it's about actively engaging in the dialogue that shapes policies for a tomorrow that mirrors our aspirations for a better sustainable future and be change actor of the future.
I am aware that these tools cannot be used by all our family members, and I do apologise, should my invitation for Call to Action be cause of frustration, however, bear in mind one of the leading and golden principles of our common path: sharing experiences, best practices, benchmarking. In this respect, let us hope these brief considerations might be of inspiration.
Cristiana Gaita, FO Team Senior Consultant Team Europe Direct network member, Italy
Dear Friends,
I had just finished my studies when I joined the Fund Operator, and it is impressive to see how these group of people, together with You all, became a Family.
From behind the scenes of the Regional Funds Online Magazine, I am honored to extend heartfelt gratitude to each of You as we draw the curtain on this programming phase. I strongly believe that, during these years, we started from a simple pdf and then quickly embarked on a journey marked by a strong collaboration, and, if I may, relentless pursuit of excellence.
It is with immense pride that I, we reflect on the transformative impact each Project has had within this community. Your unwavering dedication to pushing boundaries and embracing creativity has not only elevated the quality of our collective efforts, but has also served as a beacon of inspiration for future initiatives (I hope, but I am sure about that).
Your support and engagement have been the cornerstone of the success of this virtual Mag, a space where we hope you also found ground for further visibility. Whether through active participation, sharing insights, or lending a helping hand to fellow members, your commitment to our shared vision has been unwavering. It is your passion and enthusiasm that fueled our collective momentum and propelled us towards greater heights.
I really wish this gratitude arrives to every member of our Family. Each Project has played a unique role in shaping our shared narrative, enriching our experiences, and fostering a culture of inclusivity and growth. I believe that we, all together, have witnessed firsthand the power of collaboration, fortified by our shared vision and unwavering commitment to excellence, beyond challenges. Because, I know, sometimes we have pushed you. But… I am not sorry about that : our Mag is really an innovative product and I hope these efforts won’t be forgotten.
As we move into the next chapter of this journey, whichever it is, please carry forward the spirit of innovation and collaboration that defined us, pushing boundaries and exploring new horizons, thanks as well to a good level of optimism and enthusiasm!
On behalf of the Regional Funds Online Magazine, I extend my deepest gratitude to each person behind the Projects for being such invaluable members of our Family. Your dedication and engagement have been the driving force behind our collective success, and for that, we are really grateful.
Here's to the memories we have created, the challenges we have overcome, and the bonds we have forged. May our journey ahead be filled with continued growth, prosperity, and endless possibilities.
With warmest regards,
Francesca Bombarda Regional Funds Online Mag Editorial Team
All EU funds must be spent in a way that respect fundamental rights. The EU invests billions of euros in creating jobs, economic growth, sustainable development and improving people’s lives. To prevent funds from being spent in ways that violate people’s fundamental rights, the EU strengthened the conditions how funds can be spent in 2021.
A new report by the European Union Agency for Fundamental Rights looks at how the newly introduced conditions related to the EU Charter of Fundamental Rights and the United Nations Convention on the Rights of Persons with Disabilities (CRPD) can be upheld in practice. It analyses the potential role of national human rights institutions, ombudsperson institutions and equality bodies. These safeguards can advance compliance with fundamental rights. The report is based on research in 12 Member States: Bulgaria, Croatia, Cyprus, Estonia, Finland, France, Germany, Greece, Latvia, Poland, Portugal and Slovakia. FRA used desk research, national roundtables and semi-structured interviews with relevant stakeholders in 2022 and 2023. The report relies on activities of the project Supporting National Human Rights Institutions in monitoring fundamental rights and the fundamental rights aspects of the rule of law funded by Iceland, Liechtenstein and Norway through the EEA and Norway Grants Fund for Regional Cooperation.
The enabling conditions contained in the Common Provisions Regulation 21–27 may help to prevent operations that are not in full compliance with the Charter and the CRPD from being funded in the first place. This requires Member States to take measures promised in their Charter and CRPD arrangements. Measures include improved fundamental rights training, raising the awareness of all key players in the cycle and ensuring the availability of practical tools to check Charter and CRPD compliance. Action is particularly required at local and regional levels.
There are three main findings related to participation, capacity and resources, and the complaints mechanism.
1. To make better use of the expertise, data and findings of independent fundamental rights bodies and CSOs specialising in fundamental rights, their involvement needs to be greater and more meaningful, including at the initial stages of the funding cycle. Although many of these actors were involved in the previous programming period, greater efforts are needed to ensure that their participation is encouraged, meaningful and facilitated.
2. It is important that all actors involved, including independent fundamental rights bodies and specialised fundamental rights CSOs, are provided with the necessary extra human, financial and technical resources for this new role.
3. Lessons need to be learned from evaluations and complaints procedures to ensure that the enabling conditions on the Charter and the CRPD make a real difference in the activities and operations that the EU is funding. Member States need to ensure that their complaints procedures are sufficiently effective to identify any violations that occur and deal with them effectively.

Outcomes (as of 30/9/2023)
→643 Jobs created
PL 146 , IT 74 , SP 194, GR 227
→840 in Active job searching (or returned to schools/studies)
PL 33, IT 347 , SP 291, GR 184
→380 in the process of starting their own business
PL 18, IT 143 , SP 165, GR 66
→ in total 1804 out of 2644 (two out of three – 68.23%)
Scaling trust-based partnership models to recharge youth entrepreneurship: Supporting underserved communities with innovative entrepreneurship support Instruments (TPM-RYE) Project, Benefits from €3.3M grant from Iceland, Liechtenstein and Norway through the EEA and Norway Grants Fund for Youth Employment. The aim of the Programme is to activate unemployed youth to access the labour market and promote entrepreneurship.

Young Entrepreneurs Succeed (YES!) is a trust-based collaboration involving 8 public and private institutions from Germany, Greece, Italy, Poland, Spain, and the United Kingdom with extensive experience in promoting entrepreneurship among disadvantaged youth.
The program's aim has been to offer hope and opportunity to disadvantaged youth in Europe. With the backing of the EEA and Norway Grants Fund for Youth Employment, this initiative has made a significant difference in the lives of thousands of young people across the region.
Since its launch, the project has proven to be a catalyst for change, promoting entrepreneurship and providing young people with the necessary tools to thrive in a competitive job market.
The project's essence lies in its holistic approach to addressing youth unemployment and fostering entrepreneurship. Through strategic partnerships with institutions in Germany, Greece, Italy, Poland, Spain, and the United Kingdom, which have acted as implementing partners and experts, Young Entrepreneurs Succeed has offered a diverse range of services ranging from training and counseling to funding and mentoring. These services are specifically designed to meet the unique needs of unemployed youth, providing them with the support they need to turn their ideas into reality.
The project goes beyond providing practical services; it has also created a website https://youngentrepreneurssucceed.com/ that serves as a centralized resource for young entrepreneurs. Through this platform, participants have access to a variety of resources, including interviews with experts, practical tools, and inspiring beneficiary interviews. The interviews were designed to capture authentic testimonials and meaningful insights into how the project has impacted the lives of beneficiaries. The aim was to understand the challenges they faced before participating in the project, how the project has benefited them, and what advice they could offer to other young people in similar situations.

Additionally, within the framework of Young Entrepreneurs Succeed and over the past 5 years, numerous workshops and conferences have been organized across Europe, providing young people with the opportunity to connect with each other and learn from experts in the field of entrepreneurship. These events have been instrumental in fostering collaboration and idea exchange and have greatly contributed to the overall success of the project. For example, the "Youth Employment Summit," held in Barcelona, attracted more than 140 attendees. During the event, important topics related to youth employment were discussed, successful experiences were shared, and new strategies to address challenges in this area were explored.
The final conference of the Young Entrepreneurs Succeed project was in Athens. As the culmination of the program, it was titled "It's all about NEETs!" The event continued with a review of the history of the YES! project, from its inception to the impact it has had on various European countries during its active time.


Another significant milestone is the premiere of "Lion Dreams," in collaboration with the Superior School of Cinema and Audiovisuals of Catalonia (ESCAC) to produce an emotional short film. The film project reached a significant milestone by garnering interest from a distributor who committed to showcasing it in 26 festivals, including some that are qualifiers for the Oscars. This initiative not only provided a platform for creatively sharing the project's narrative but also increased its visibility and potential reach.
However, in 2020, the project was affected by Covid-19. One of the significant challenges we had to face due to Covid-19 was transitioning all services online and engaging the target audience to join them online from home. It was also challenging to keep the project team united despite social distancing. Despite the difficulties, we managed to continue sharing knowledge, activities, and learnings through the screen.
Now that we have overcome this post-Covid stage, the project's results speak for themselves. Over the past five years, Young Entrepreneurs Succeed has created 643 jobs and facilitated active job search or return to education for 840 young people. Additionally, 380 young people are in the process of starting their own businesses, demonstrating the lasting and positive impact the project has had on the lives of thousands of young people across Europe.
As we celebrate five years of achievements and successes, it is important to recognize the hard work and dedication of all those involved in the project. From partners to young entrepreneurs themselves, each has played a vital role in the success of Young Entrepreneurs Succeed. Looking ahead, we are excited to continue our work together, empowering more young people to pursue their dreams and build a more prosperous future for themselves and their communities.



1. What is Microfinanza Srl and why does it originate? What was the original objective?
«Microfinanza was established in 2000 as a result of a group of professionals coming from diverse backgrounds (international cooperation, ethical finance, others from research) who began collaborating together, also considering the need for a structure/organisation that would function as a capital company, thus more technical, capable of acting in the field of financial inclusion. The theme of microfinance originated in a more non-European context, but from this arose the idea of providing technical assistance services primarily to microfinance institutions around the world and then also to other public or private organisations/institutions interested in developing initiatives in this field. Time has passed, but the confirmation of our mission is still present, also because some questions are still very relevant and indeed not yet resolved, I think for example of financial inclusion, and different problems have grown in Europe - especially starting from the 2008 crisis (with poverty, social exclusion) - which also reflect strictly on financial issues».
2. Has there been an evolution then?

«Yes. And it primarily concerned the target audience; a problem related to the issue of migrants, new citizens, and young people who structurally have always had problems accessing financial services has arisen, but with the evolution - and the change in relative conditions - of the labor market, they also face other consequences. Think, then, of all the people who do not have a stable employment contract, or who are in a phase of job mobility, or the NEETs who experience a condition of great uncertainty between the end of their educational experience and temporary inability to enter the job market, or again think about the issue of women, of people over 50 experiencing professional 'recycling' and the difficulty of acquiring new skills».
3. How does financial exclusion arise?
«Surely in some cases, it stems from a lack of credit income history. A typical case is that of a migrant who arrives in another country without any income history or memory, and in that case, it is extremely difficult to have any credit income scoring. The same goes for young people: in many cases, ours is a society with little mobility, little fluidity, or the ability to provide opportunities.
If we think instead of more recent periods, the main phenomenon concerns over-indebtedness: people who, for various reasons, had good access to financial services and who had debtor relationships, find themselves with an unsustainable debt burden and, consequently, they are thrown out of the financial system. It is a panorama that has led us to pay more attention to more strictly European and, obviously, also Italian issues».
4. The YES! Project: why was it born?
«The project was born because Microfinanza has been active in the European reality for a long time, we are among the founding members of the European Microfinance Network (EMN), thanks to which we have also met various European partners. We have been operating in the European labor market for a long time. Unfortunately, the issue of NEETs in Italy is dramatic in terms of numbers, making us ‘first among the last’. With some specific experiences in certain territories, for example a project carried out with Sicilian partners, we realized how important it was to talk to young people about topics such as business creation, business start-ups, etc. So, the idea of participating in this Project was born: on the one hand, thanks to our European networks, on the other hand, thanks to our fieldwork».
5. Is it possible to measure the practical feedback/satisfaction from the targets?
«Dealing with financial inclusion has made us realise that the issue often has to do with what we call 'non-financial services', i.e., all those services that are able to build skills, soft skills, to help people understand where they are and what kind of project they represent. If we think in terms of beneficiary satisfaction, two different levels should be considered. On the one hand, it is necessary to help the target understand their own need, which is not trivial but often overlooked. And the experience with the YES! Project for us was very interesting from this point of view because from the beginning, we realised how much disorientation there was. On the other hand, this very important orientation work must be followed by training, coaching, and mentoring. The other issue that emerged is that doing this human capital building work is preliminary regardless of whether we think in terms of business, entering the job market as a worker, or resuming a training path».
6. It’s as there is a need to resettle the social system and people to help them fit into a context.
«Yes, also because the phenomenon of NEETs is as if it arises when one finds oneself in a desert. And the more difficult the situations are, as in Southern Italy, the more the phenomenon increases. And another aspect, we discovered it by analysing the territory of Vicenza (our local system) is very relevant: the phenomenon of NEETs is certainly present in the Northern regions, but when it does appear, it has very strong characteristics of severity and social distress at the level of marginalisation of people in society».
7. Is it possible/desirable to replicate these services?
«What we have always hoped for is that projects become a starting point, a boost for something that should be assumed at the level of social infrastructure, public services, local, etc. However, this is perhaps the most difficult part. And we should ask ourselves, especially in terms of funding, how social infrastructure is created, how the handover of a particular project is managed. Another fundamental thing in terms of replicability would be to work more on networking: there are many entities that implement certain services but, many times, are not in contact with each other».
8. Microfinanza’s future plans, also with a view to consolidating the results achieved with the YES! Project?
«We will continue, also eventually with other European projects that remain very close in terms of themes, targets, and services. It is not always easy to find the right methods or channels to guarantee sustainability and intensity of services, but the 'red thread' remains».
9. Should we start thinking about other targets, in addition to NEETs for example?
«In the meantime, it would be necessary to consider individuals in the last or even penultimate year of school, already at that moment it would be necessary to understand how to intercept, for example, school dropout, making sure that there is adequate professional orientation at the end of compulsory schooling or high school. There are many fragile young people in that context. Furthermore, special attention should be paid to foreign individuals. In this case, some problems/difficulties are accentuated, starting from language or the acquisition of some specific codes of a society (fundamental issues for not being marginalised). Finally, on the issue of NEETs, there is an important aspect that we have found: the European definition is no longer enough. We have learned that the more fragile the context, the longer the age range extends. At least individuals up to 35 years old should be considered. On a methodological level, it would be interesting if Donors in the design phase carried out a sort of public consultation, even more involving the 'old' partners, to understand what the main lessons learned are. Because we have analysed and touched on many relevant aspects».
11.000+ Individuals reached through various ways (phone calls, emails, meetings, etc.)
536 Newsletter Subscribers

3 funded PhD students
3 Transnational Reports
11 Scientific papers

735 Vocational profiles delivered
1000+ Individual coaching sessions
59 Workshops
4 Transnational Employment Centres
Youth Employment Monitor
E-Learning Platform
E-mentoring tool Workspaces

2 Online Training Programs
4 Trainee’s handbooks/manuals
1.163 Beneficiaries (Cyprus: 318, Greece: 312, Italy: 265, Spain: 266)

2300+ Followers
660+ Posts

The YOUTHhare Project, has been a member of the EEA and Norway Grants family since its beginning in 2018. It is an interdisciplinary project, whose goal is to reduce the NEET (Not in Education, Employment or Training) rate in coastal and island regions of Mediterranean EEA (Cyprus, Greece, Italy and Spain), by advancing young NEETs skills in trans-locally resilient economic sectors (such as sectors in circular, social and sharing economies). At the beginning, the target group of the project were young NEETs, Inactive Women and Migrants, yet eventually the target group expanded to generally inactive young people. The Project’s Lead Partner (University of the Aegean), along with its co-partners from Cyprus, Spain and Italy, collaborated with Training and Consulting Organizations, as well as an Enterprise Networking Organization, and an Expertise Partner in Labour and Social Research.
But what is the project’s contribution/impact to the reduction of the phenomenon of NEETs and youth inactivity / (un)employment?
First of all, researching them is a very crucial step, to further understand these phenomena and examine ways of reducing them! Thus, the Project consists of both experienced and new scientists studying issues on youth (un)employment, NEETs and pertinent policies, thus creating the YOUTHShare TransNational Research Centre. It consists of funded Phd Students studying these pertinent issues, released papers in Scientific Magazines and reports, and contributions to the writing of Chapters in Books, such as in the case of the upcoming book entitled: “Inequalities, Youth and the Labour Market. NEETS in Southern Europe”. Last but not least, in the context of the further education and training, they have produced a number of handbooks and manuals.
Secondly, the Project has conducted a number of Online Training Programs, following with Certifications by the University of the Aegean. The trainings were being conducted through the E-Learning Platform, which provides training and acquisition of skills regarding social economy, IT and web based economy, and the resilient sectors of the Mediterranean economy, completely free of charge. Additionally, it has created a number of Transnational Employment Centers, mentoring services to further help new entrepreneurs put their ideas into practice, and Apprenticeships to positions related to resilient sectors. Finally, the Project has released a series of tools and platforms, in order to contribute to further studies of the issues mentioned above, and reduction of the number of unemployed/ inactive youth:
• The Youth Employment Monitor, that provides insights on the data related to the Mediterranean EEA’s youth (un)employment, inactivity, NEETs and so on (on a national level), along with a National Forecasting tab; the Download Data User Interface, where one can download custom data; and the Youth Guarantee Interactive maps for each country of the Mediterranean EEA, followed by its respective Youth Guarantee report.
• The Join2Share Platform that includes: The E-Learning Platform mentioned above, the e-mentoring tool, a tool for people who seek mentoring for the development of their professional career; and last but not least the Workspaces tool, a platform that facilitates the identification of suitable and available co-working spaces, located in all of the YOUTHShare project’s countries (Greece, Cyprus, Italy & Spain).
In our upcoming articles, we will delve into the Best Results, and the Best Practices of the project. Last but not least, we will reflect on the considerable significance the Regional Funds Online Magazine has had for us, both as a project and as individuals engaged in its mission.
We will always be at your disposal for any future collaborations and synergies, so feel free to stick around! Visit us on our website (by clicking here or by scanning the QR code) to find out more, or feel free to contact us directly at youthshareproject@gmail.com !
The YOUTHShare Project Team

The YOUTHShare Project, had managed to archive most of its main goals, and is still going strong!
So let’s talk by numbers!
During the implementation of the Project, 3 PhD students had me funded, at least 3 Transnational Reports have been created, and at least 11 scientific papers have been released in scientific magazines.
The project has come in touch with more than 11.000 people during its implementation, in a plethora of ways (phone calls, e-mails, meetings, coaching sessions and so on), has delivered 735 vocational profiles, has created more than a thousand individual coaching sessions, as well as 59 motivational workshops and 4 Transnational Employment centers in Greece, Spain, Italy and Cyprus. Through its two Online Training Programs and its four Trainee’s handbooks and manuals, the number of the YOUTHShare Project’s beneficiaries is 1163 young people, (318 from Cyprus, 312 from Greece, 265 from Italy and 266 from Spain).
4 important digital tools have been created, providing solutions for a more targeted study of issues regarding youth (un)employment and NEETs, as well as for a further development of young people’s career.
Last but not least, on a more “social” impact, the social media pages of the Project had gained a total number of 2300 followers and 661 posts.
During the implementation of the Project, as well as its evaluation, the YOUTHShare project has implemented some best practices in order to achieve its goals, as effectively as possible. However one thing is for sure: the experience and knowledge gained through this constantly developing and changing process, had become one of the greatest lessons learned and a motive for a further development of pertaining best practices. The importance of versatility, collaboration, human-centered approaches, and continuous learning had become clearer than ever.
Here is a brief description of the best practices:
• Continuous Learning and Adaptation. Acknowledging that the process of program management is a learning process, emphasizing the importance of adapting strategies and being proactive to deal with unexpected impacts (such as the pandemic).
• Partnership and Collaboration. Highlighting the significance of developing partnerships between heterogeneous partners and multi-scale networks, allowing for wider tracking and data exchange methods. Also, emphasizing the importance of trust-building mechanisms within partnerships.
• Customized Support Plans. Recognizing the need to develop customized support plans to surpass the various obstacles of the labor market entrance, faced by difficult-to-reach young people.
• Integrated Approach. Advocating for an integrated and long-term approach for mapping the field of intervention, which is essential for addressing the needs of diverse subgroups effectively.
• Empowerment and Autonomy. Promoting autonomy between partners by delegating responsibilities, while simultaneously bridging them. Additionally, adopting a motivational management approach, in order to inspire both the partners, and the wider network.
• Developmental Evaluation Perspective. Encouraging a developmental evaluation perspective, focusing on continuous learning and improvement throughout the implementation process.
• Feedback and Iteration. Gathering feedback from key actors (such as local managers, researchers, and NEETs), and using it to iterate and improve project design and implementation.
• Human-Centered Approach. Considering the feedback and satisfaction of NEETs - the project's protagonists-, ensuring that their needs and preferences are addressed (such as extending the duration of internships by their requests).
• Visibility of Results. Recognizing the importance of demonstrating practical results to stakeholders, such as local managers and key actors, to showcase the project's impact and effectiveness.
• Selective Partnership. Considering feedback from researchers regarding the number of partners involved and aiming for a more exhaustive selection of partners to ensure a more evenly distributed workload.
As we were writing the very last articles for the magazine, good news kept on coming, and the post-implementation era couldn’t become better. This proved that our Project’s implementation period might have come to an end, but it's never too late to keep on thriving! Thus, we couldn’t help ourselves but write a “bonus” article about it.
To that end, we are more than excited to announce, that the YOUTHShare Project has officially been added as a case study at the “Observatory on Digital technologies in Career guidance for Youth” (ODiCY) of the “Organisation for Economic Co-operation and Development” (OECD)!

Feel free to check out the YOUTHShare Project’s Case Study, by clicking here!
Anna Saroukou YOUTHShare ProjectAmongst the plethora of interesting case studies submitted at the Observatory, the YOUTHShare Project presents its goals, and resources that can contribute to the further development of young people’s working life (including the Sharing Economy ePlatform, eLearning platform and Youth Employment Monitor). Additionally, it describes the methods and technologies behind the initiative, that contribute into making guidance more effective and efficient for the youth. Finally, potential challenges and barriers are being mentioned, as well as some additional details regarding the resources’ recognition, evaluation and so on!
As we approach the closing chapters of the YOUTHShare project, we take a moment to express our profound gratitude to the Regional Funds Online Magazine, a steadfast companion in our collective endeavor. Throughout this transformative journey, the magazine has been more than just a conduit for information; it has been a cornerstone in narrating the story of our collaborative efforts. As we celebrate the achievements, acknowledge the challenges, and reflect on the impact of our initiatives, the magazine has served as a vital platform for sharing these narratives.
In these pages, our experiences found a voice, our successes were spotlighted, and the diverse contributions of each partner were acknowledged. The magazine has played a pivotal role in fostering a sense of community among us, creating a space where ideas flourished, and collaborative spirit thrived. As we close this chapter, we extend our sincere appreciation to the Regional Funds Online Magazine for being a beacon of inspiration, a source of knowledge exchange, and a testament to the collective achievements within the YOUTHShare project. The magazine has played an integral role in uniting us as partners, and we look back with gratitude for the collaborative journey it has encapsulated.
To the readers who have engaged with the magazine, thank you for being part of this vibrant dialogue. As we move towards the closing stages of YOUTHShare, let's carry the lessons, insights, and shared experiences forward, ensuring that the impact of our collective efforts endures beyond the project's conclusion.
Aimilia Markaki, KAM Nesc, Greece
As I reflect on my experience contributing to the Regional Fund Online Magazine, the first that comes to my mind is the sense of gratitude for the opportunity to share insights and perspectives on the YouthShare project addressing Youth Employment.
First and foremost, I want to express my deepest thanks to the entire editorial team and to our communication manager for entrusting me with the task of writing several articles on such an important topic. It has been an incredibly fulfilling journey to delve into the complexities of youth employment, explore innovative solutions, and shed light on success stories and challenges alike.
The Regional Fund Online Magazine has been more than just a platform for me; it has been a conduit for meaningful dialogue, a catalyst for change, and a source of inspiration. Collaborating with the talented individuals behind the scenes has been a true pleasure, and I am continually impressed by the dedication and professionalism demonstrated by everyone involved.
Moreover, seeing the impact of our collective efforts in raising awareness, fostering discussions, and driving positive action towards addressing youth unemployment has been immensely rewarding. It is a proof of the power of journalism to effect change and make a difference in the lives of individuals and communities.
Rosa Messuti GAL La Cittadella del Sapere Italy
"The challenges that contemporary society poses to organizations and projects seeking dissemination are numerous. The world of communication has become dynamic and although there are many opportunities, often the difficulty lies in finding and seizing them. The Regional Funds Online Mag positions itself right in the middle between projects, organizations and the society. The Regional Funds Online Mag organised and showed information where the results of the projects were explained to give the society new ideas and motivation. Society needs to know that they can count on people and online magazines that can support and help them in their process of growth. It is important to continue with effective communication activities to reach as many people as possible who could benefit from the Regional Funds, its material and tools."
"The challenges that contemporary society poses to organizations and projects seeking dissemination are numerous. The world of communication has become dynamic and although there are many opportunities, often the difficulty lies in finding and seizing them. The Regional Funds Online Mag positions itself right in the middle between projects, organizations and the society. The Regional Funds Online Mag organised and showed information where the results of the projects were explained to give the society new ideas and motivation. Society needs to know that they can count on people and online magazines that can support and help them in their process of growth. It is important to continue with effective communication activities to reach as many people as possible who could benefit from the Regional Funds, its material and tools.”
Jose Fernandez, AEII, Spain
Started from the bottom, while trying to find a job and knowing that freedom of speech was getting more and more strict, I was not even thinking that I would be in a position to write about issues regarding youth (un)employment. Yet here I am, contributing to a magazine- a voice that provides a plethora of perspectives thereby broadening our knowledge. A voice that shares other people and project’s achievements and solutions on the pertaining issues mentioned. In other words, a versatile voice that includes everyone and more importantly gives the opportunity to make our voices be heard, regardless of our reputation!
It is great to finally see that there are many more people that share the same values as me and have the urge to express themselves and bring youth (and not only) (un)employment issues to the surface! It somehow gives me courage to keep on expressing myself and dare to talk and stimulate discussions on employment -and in my case youth (un) employment-. I would confidently say that it got me “out of the box” and gave me the feeling that my voice DOES MATTER! For all these, I will be forever grateful for having the opportunity to be a part of this initiative, introduced through my journey with the YOUTHShare Project. I will always turn back to the magazine’s issues and have a glance on all these perspectives presented and all these wonderful goals archived! Afet all, it is important to look back on these collective efforts, and remember that our voices, no matter how humble, have the power to shape the future!!
So for one last time, I am expressing my gratitude to the Regional Funds Online Magazine once again, hoping that this legacy will still keep on going and develop to something grand and legen…wait for it… dary!
Anna Saroukou YOUTHShare Project, Greece
Back in 2021, when this whole journey started, we planned a research and analysis project that would contribute to a better evaluation of existing youth employment policies, a clearer understanding of the needs of NEETs in rural and tourism dependent areas, the potential contribution of alternative economic sectors, and provide specific policy recommendations for the future.
It was an ambitious task; but we think we managed well!
In terms of results, we have delivered the promised outputs, all contributing to a specific aspect of the research. Two Transnational Reports have been delivered, providing much-needed evidence based research. Two PhDs related to youth labor, NEETS and coworking in urban/rural spaces have passed the stage of initial submission. Eight papers have been submitted to well regarded peer-reviewed scientific journals. The Cowork4YOUTH Employment Observatory has been set up, providing data that is easy to access and process, in conjunction with the Transnational Research Network. Finally, two sets of Policy Recommendations have been produced and disseminated to researchers and policy makers.
As far best practices are concerned, we pride ourselves in having connected the world of research and policy with the the real world of the NEETs in question and of the practitioners who have to actively implement employment policies and reach out to the target groups. To this aim, our researchers have undertaken extensive field research and visited numerous organisations and stakeholders across Europe in order to get an accurate picture. Similarly, our five Open Events have all actively sought synergies with stakeholders across the spectrum, other researchers and academics, as well as other Fund for Youth Employment projects. This culminated in Athens last December where two different events were held, the one focusing on academics and policy makers, and the other bringing together practitioners from across Europe. Indeed, the ’Cowork4YOUTH: WHAT ARE THE GOOD PRACTICES?’ event brought together organisations representing 7 different countries – a total of 47 individual participants!
The impact that we hope we have achieved starts with opening up a broader discussion about NEETs and youth employment, as well as the potential usefulness of coworking spaces. Bringing together practitioners, academics and policy makers, making them aware of our findings and exchanging experiences and ideas is the first step. We have also worked to increase practitioners’ knowledge and capacity and to bring about an increased transnational cooperation on labour market issues that will hopefully forge new ways ahead in terms of practice, research and policy. Finally, the policy recommendations have been communicated and well received by policy makers and we expect that the results will soon be fused into actual policy implementation.
But of course, as much as it may sound like a cliché, the most important “best practice” is a solid consortium and a good cooperation between partners, both on the level of organisations, but also as individuals. No good result can be achieved without good collaboration.
SEPAL has brought together five European organisations from Romania, Spain, Lithuania, Greece, and Poland – in a collaborative effort to address youth unemployment and support vulnerable NEETs.
As the SEPAL project reaches its five-year milestone, we can affirm that it was based on a strong commitment, between five European partners, to supporting youth NEETs from diverse backgrounds.
• Bucovina Institute Association (Romania)
• Fundació Privada Pere Closa (Spain)
• VšĮ Žmogiškųjų išteklių stebėsenos ir plėtros biuras (Lithuania)
• Κοισπε Διαδρομές (Greece)
• Fundacja Komes (Poland)
From the beginning, SEPAL, short for Supporting Employment Platform through Apprenticeship Learning, has been dedicated to o ff ering individualised supported employment services to vulnerable youth NEETs, aged 18 to 29. Now, as we reflect on the journey and celebrate the achievements, it's clear that SEPAL has broken barriers and built pathways to success for hundreds of young people.
With a focus on inclusivity, the project has provided tailored services to individuals facing various challenges, including low-skills, disabilities, longterm unemployment, and more. By recognising the unique needs of each participant, SEPAL has been able to offer targeted support, empowering young people to overcome obstacles and pursue meaningful employment opportunities.
At the heart of SEPAL's success lies the WISE model – Work Integration Social Enterprise. This innovative approach has served as a blueprint for success, guiding the project's efforts to provide effective employment support services. Through a combination of initial evaluation, apprenticeship stages, job mediation, and more, the WISE model has enabled SEPAL to deliver comprehensive support that meets the diverse

Some of our most significant achievements:
• Supported employment services. Throughout the duration of the project, SEPAL has provided supported employment services to almost 900 youth NEETs, coming from different vulnerable groups, offering them the tools and resources they need to succeed in the workforce.
• Skills development and certification. SEPAL has offered certified courses to enhance the ICT and entrepreneurial competencies of over 200 NEETs. Additionally, the project has developed guidelines for the evaluation of competencies, ensuring that participants receive recognition for their skills and competencies.
• Collaboration with Local Stakeholders Committees. With the involvement of over 45 Local Stakeholders, SEPAL has fostered collaboration and partnership at local, regional, or national levels, ensuring that young people receive comprehensive support from their local networks.

• Capacity building. With 30 trained coaches and mentors, five functional WISE experts, SEPAL has fostered a culture of collaboration and knowledge-sharing, enriching the employment landscape in each participating country.
• Innovation and sustainability. Innovation lies at the heart of SEPAL's approach, as evidenced by the development of various instruments and resources, including the SEPAL E-platform, Innovation Book, Apprenticeship Book, White Book, and Coach Guidelines, Working with vulnerable groups Guidelines, Evaluation of competencies Guidelines, SEPAL Coalition. These resources not only enhance the effectiveness of SEPAL's interventions but also pave the way for long-term sustainability and scalability.
• VR technology. Equipped with VR glasses, youth NEETs engaged in interactive experiences covering basic tasks and challenges, providing valuable insights and practical skills in a secure virtual environment. Through simulations as medical assistants, salespersons, housekeepers, and more, participants gained confidence and readiness for their careers.
• NEETs Academies. The three Academies, organised under the SEPAL Project, being facilitated by Social Firms Europe CEFEC network, represented an opportunity for cross-border dialogue (between NEETs and experts across Europe) and knowledge exchange, and played an important role in evolving innovative solutions for the challenges faced by youth NEETs.
• The first edition took place in October 2021, in Gura Humorului, Romania, and marked the genesis of a collective effort, with youth NEETs that developed business plans for their social enterprises, generating innovative ideas such as recycling IT equipment, creating sustainable clothing from recycled textiles, engaging in organic gardening, empowering women through a circular economy clothing company, and establishing an upcycling shop with jewellery made from e-waste, emphasizing sustainability and social inclusion.
• The edition that took place in May 2022, in Siauliai, Lithuania, was the second encounter aiming at collaborative learning and exchange of ideas and practical solutions in the realm of social enterprises. Topics covered included wood recycling, IT reuse, textile reuse and women's empowerment, bio markets, and green business practices aimed at achieving CO2 neutrality.
• The third edition that took place in September 2023, in Itea, Greece, focused on connecting participants with local production and entrepreneurship in rural areas. Thematic workshops on honey production, olive harvesting, and leather processing enriched the holistic learning experience.
• Creating synergies and exchanging good practices. SEPAL fostered collaboration and knowledge exchange among almost 30 projects funded by the EEA and Norway Grants – Fund for Youth Employment, reaching more than 20 European countries, and 50 organisations/ institutions. Through online and face-to-face interactive events, “Let’s NEET together!” facilitated the creation of synergies, allowing these projects to share their innovation, tools and methods, and success stories. During 11 online gatherings and 2 face-to-face meetings, Lead Partners and Beneficiary Partners, Local Stakeholders, and experts gathered to discuss challenges, brainstorm solutions, and learn from each other's experiences.
• The final event in the heart of Europe. The SEPAL Final Conference was held at the European Parliament, in Brussels (Belgium), on the 6th of November 2023, an represented a moment to celebrate our efforts in supporting youth NEETs employment across Europe. Organised by Bucovina Institute, the Lead Partner, this event convened experts in the field, European decision-makers, FO representatives, and all partner organisations within the SEPAL project. Hosted by MEP Dragoș Pîslaru, the conference addressed crucial priorities for youth NEETs, emphasizing the development and validation of skills through apprenticeship and learning-on-the job stages, and the importance of inclusive support systems. With over 50 participants from 28 organisations across Europe, including representatives from the European Parliament and the European Commission, the conference facilitated discussions and presentations by experts in various fields, showcasing innovative strategies and collaborative efforts to empower youth NEETs. The event underscored the significance of European collaboration in addressing social and employment challenges, reaffirming the commitment to creating opportunities and fostering inclusivity for all community members.

Our statement:
The SEPAL project consortium continues to advocate for the empowerment of youth NEETs in Europe. Our focus lies in supporting those facing barriers in education, training, or the labour market, including individuals with disabilities, migrants, refugees, and the long-term unemployed. Through apprenticeship and learning on the job stages, we aim to validate skills and provide practical pathways to employment. However, sustaining these initiatives requires additional financial support. We propose urgent financing for youth employment support services, improved communication between educational institutions and labour offices, and the creation of a European Fund for apprenticeship programs. Moreover, we emphasize the involvement of social enterprises and the promotion of green initiatives to enhance job opportunities and foster a skilled, empowered workforce.
Conclusion:
SEPAL concludes its five-year journey with pride in its accomplishments and a renewed dedication to its mission of breaking down barriers and building pathways to employment for youth NEETs. The project has empowered hundreds of young people, enabling them to pursue their goals and aspirations. Through collaboration, innovation, and unwavering commitment, SEPAL has made a significant impact on creating a more inclusive and prosperous society.
The SEPAL project was a milestone for our Cooperative and for each individual involved. Supporting the employment of vulnerable groups has always been a primary objective of our organization and this program has given us a special impetus to further develop and improve this objective.

The project gave us the opportunity to network within and outside Greece with organizations and institutions that support young people who are out of education and employment. It gave us the opportunity to meet young people with values and perspectives, who needed a chance to enter the labor market and showcase their skills. One of them was Maria F., who through the project received training in the field of aesthetics and through her cooperation with our WISE Expert, was able to receive a significant amount through a young entrepreneurs grant and start her own business. Also, Anastasia F., who after training in aesthetics, found her opportunity in the labor market, even though she had no previous experience or studies.

Another example is young people with autism spectrum disorders, who through the program have been given the opportunity to be trained in specialized computer and social entrepreneurship programs. Opportunities for these young people are limited and the SEPAL project has given them the opportunity to develop skills that are useful for their future.
We had young people trained in different areas such as cleaning, gardening, cooking, 3D printing, secretarial support, crafts, etc. We had WISE Experts and Coaches who supported the youth in their efforts to develop skills and find employment. We had LSCs, who played an important role in implementation by o ff ering referrals for young NEETs and employment and training opportunities.



Special mention should be made of the project's funders, the lead partner and our partners. Our cooperation throughout the 5 years has been exemplary. The funders and their monitoring mechanism have always been supportive and consultative, facilitating our project implementation. Our lead partner was excellent and provided substantial support from the beginning to the end of the implementation. Our partners gave their best and through a constructive and excellent collaboration, we were able to deliver successful results. The creation of new tools, international training meetings, webinars, exchange of best practices, creation of audiovisual material, were key factors for the success of the project.

The impact of the project on our beneficiaries and within our organization is strong and significant. The project employees developed new and strengthened many of the skills they possessed. They networked with local and foreign professionals and gained many experiences that will be absolutely useful in their careers. At an organizational level, our visibility through the implementation of the project has increased significantly across the social economy sector. Within the framework of our operation, and especially through the operation of the Office of Supported Employment of KOISPE Diadromes, we wish to keep SEPAL alive, using the tools and practices developed in the project.


At the end of the day, the most important thing is that the experience of implementing such a large and important project leaves an indelible imprint on our daily lives and our professional careers. The memories and stories created are many and will follow us forever. We look to the future with optimism and continue with even more desire for the implementation of new initiatives, always focusing on supporting young people and vulnerable groups. The SEPAL project is for us the basis for more actions and innovative initiatives.

• 120 jobs created
• 92 young people (direct beneficiaries) have secured a green job
• 15 new start-ups (direct beneficiaries)
• 180+ career advisors and teachers educated on green jobs
• 120+ SMEs and business associations informed on the benefits of green skills
• 4,100 youth (15-19) have learned about the opportunities in green jobs
• 35,000 general public have been reached
• Training material and e-learning in 10 subjects
• Stakeholders engaged, reaching all the way up to the European Commission and the UN ESD committee
• 2nd place in EU Sustainable Energy Week Awards, Youth Category, 2020
• 2nd place at the European Network for Innovation for Inclusion Awards 2022



The first meeting took place in Hardanger, and among many things we visited Campus Hjeltnes, where students have been taught about fruit and greens for over 100 years. The school has been through a lot of changes during the years, but always looking ahead. The latest achievement is the implementation of a new study programme that started in January 2024 – the Pommelier study. It is expected that there will also be an exchange programme for students from other universities and countries.
We visited Syse Gard – a farm in Ulvik, that is one of the partners on the Cider route. All the farms on the Cider route have small shops selling cider and other farm products, such as fresh fruit, meat and apple juice. The owners presented the history of the farm and prepared a tasting with their food combined with their cider.
The Hardanger cider festival is traditionally organized every autumn in Øystese, Hardanger. The festival brings together local cider and food producers that want to present their products. We had a stand at the fair and presented the project to local people. We also had the chance to meet the locals, try local food and drinks and enjoy the typical fair.
The Cider cluster was initiated in 2019 by the Hardanger Cider Association, and financed by local banks, Vestland County, the County Governor and the producers themselves. The commitment among the producers is very important as they all work for quality and are the local government for “Geographical indication protection”. The cluster stimulates higher value creation and works towards solving issues with the government.
They started Taste Hardanger – a cider selling experience in packages, which was very well accepted by the visitors. In the future rules and regulations will be addressed in order to affect politics, market and sales and make a positive change in this area. One big obstacle for producers of alcoholic beverages is the Norwegian law and the prohibition of alcohol commercials, therefore the stories of the producers cannot be shared to people.


At the end of March our team and students from University of Nova Gorica went on an educational exchange visit to the gorgeous Slavonia. The team from the Faculty of tourism and rural development (FTRR) presented their learning process from the basics of planting vines, grape growing and further processing of grapes into wine and to bring it to another level, they learned how to pair the wine sorts with different types of food. The research process is held at the premises of the university and at the university’s wine cellar in Vetovo, which we had the chance to visit. Students from Croatian FTRR and Slovenian UNG jointly prepared food and wine pairing dinner for all project partners using the local ingredients and wine from both countries. Students and team members were shown the Požeška kuća museum, a local distillery and three wine cellars.
We had some amazing days in Vipava Valley - visiting this beautiful University of Nova Gorica, which is located in the Lanthieri mansion in Vipava. The laboratory and fermentation rooms and equipment have been presented as well as the procedures of soil preservation, fermentation, etc.

We visited one of Slovenia's finest wineries that produces wine by using the biodynamic technique, the Guerilla winery. One of the local tourist attractions is the Wine train ride that combines historical tour with food and drink pairing. This kind of attraction gives a great impact on the local area as it connects local businesses with local people and together, they present the area and its typicalities.
The traditional event The Spring of Tourism is held in Vipava Valley every year in springtime. The event brings together tour operators from all over Europe, local farm representatives, accommodation and enogastronomica providers and other interesting parties that work and live in the tourism sector in the area of Vipava Valley and wider.
We presented our project on a stand, offering the taste of Hardanger – cider from Arita Åkre from Åkre Gard. Before that, Arita held an inspiring speech about the importance of connections in the local area and about working together as a strong unit. The feedback from the visitors was very positive and the possibility of tasting cider was an outstanding experience for local people, because they are used to wine tastings and many of them never actually tasted cider at all.






Another educational exchange visit was held in North Macedonia in June 2023. Our project partner, Tikveš winery has several estates where they grow vines and produce different types of wines. Besides visiting the boutique Lepovo domain and the highest Barovo domain we visited the main Tikveš winery with its laboratories and restaurant where we tasted exclusive dishes combined with their best wines.


During our stay we visited the local markets that are located in small squares around Oslo and our partner Nofima's offices in Ås. Nofima operates in many different areas and one of them is Sensory sciences.
The roots of our project are in Hardanger, so it is an obligatory stop. During our visit it was the period of the beginning of the apple ripening and the whole Hardangerfjord smelled of good, crispy and tasty apples. The Hardanger juice and cider factory in Ulvik was one of the first farm to become a professional cider producer in the area, established by Nils Lekve. We took the walking path between the orchards in Lofthus and the Cider safari boat. While on it, we met the People of the North team and made an interview for their TV show presenting our project.


The identification of sensory properties in food gives the scientists the answers on how sensory properties affect consumer acceptance and how the sensory properties of healthy food can be adjusted to ensure that consumers like the products, and thus choose the healthy alternatives. We visited the laboratories and blind tasting rooms and, as they have a strong collaboration with the local university, we also visited the campus.

Every year in September in the very centre of Bergen there is a traditional Matfestival where farmers and producers present their food, drinks and other products. The festival also has one part dedicated to children where they can learn, see and try different types of typical food and drinks. During the festival there are many courses for pairing food with cider, gin, beer or other drinks and other courses. Bergen is also known for its fishing history and their traditional fish market is worth a visit. Besides being very well stocked with different sea food it also offers a variety of dishes based on seafood.


This has been a strong project with a good foundation for further collaborations and we are already looking for new ways to work together. As an example, we are facing a newborn project AGROTUR+ that includes transferring the Norwegian knowledge to Slovenian cider producers. We will work for mobility options for students from UNG, FTRR, also from Norway to Croatia and Slovenia. We transferred knowledge, best practices and procedures to each other, ready to make changes in our own countries.
The Regional Cooperation Magazine offered our project the possiblity to express ourselves and to present our achievements and results, and, perhaps give people an idea to work on new, expanded ideas that were founded on our results. Besides that, we expanded our network and met incredible, future oriented people. We are open for new collaborations and new project ideas and hopefully we will form a new partnership in the future.
Nine international partners, one challenge: the implementation of a project that promotes inclusion for children with developmental disabilities through sports, over the course of three years.
Countries with different cultures and customs, United Kingdom, Iceland, Poland, Romania, Montenegro, Slovakia, Lithuania and Bosnia and Herzegovina, have come together to fulfill a common goal, offering important help in improving cognitive, social skills and motor skills of children with disabilities.
With great plans and hopes, to involve more than 5200 children and young people with and without developmental disabilities, we all planned sports events, workshops, health forums for the families of the children in the project, in order to promote inclusion in the communities we each come from.
We set out to contribute to the education of coaches and volunteers in terms of creating a relationship of trust with young people with developmental disabilities and offering help in terms of the integration of children as part of a team, to organize sports events or competitions with and for the children, for the little ones to regain their confidence in their own powers and to develop their sports skills, to restore the parents' confidence in their children, whether they are with or without intellectual disabilities.
At the end of the project, we can talk with more detachment about the lessons we have learned with the implementation of this project. Even if one of the challenges was the Consortium of the nine partners itself, implementing the same type of activities for its own beneficiaries and recording the results, this was still not the most significant.
Starting March 2020, we have all been faced with a unique and unprecedented situation: the Covid-19 pandemic. In the new conditions imposed by the pandemic, scheduled sports events and group meetings have been postponed for several months in a row. Some of them were moved online, and the results were delayed.

But with all the challenges, the feedback about the project is as good as possible. Here are some of the partners’ opinions at the end of the three-year project:
Anna Karólína Vilhjálmsdóttir, National Director Special Olympics Iceland
What did you like most about this project?
For us, it was an opportunity to learn about the projects and programs that were running with supports from the Grant. It was also the opportunity to work together towards an Inclusive Europe.
How was this project different for all the other projects you have implemented?
For SO Iceland, we have not worked before with programs from East Europe and this was a very positive experience. We felt that the registration system was more complicated than needed to be.
Did you feel or see that the project had an important impact on your activity? How?
The project had an important and positive impact on our clubs and athletes, as well as starting as a new opportunity, raising awareness and focusing on inclusion.
Did you feel that the project had an important impact on your beneficiaries?
As an expert partner, SO Iceland confirms that the project had a very important impact on the beneficiaries and had registered a high-level result on all activities, when looking at the new opportunities the athletes were given through this project.


What did you like most about this project?
Through the project we provided children aged 6-12 years with developmental disabilities and their peers without disabilities opportunities to play and compete in Unified Sports such as football and basketball and to improved their skill and ability level.
Thus, we organized a huge number of Family Health Forums which offered an environment where parents and caregivers could gain direct access to health information, resources, education and inclusive activities, but also empowered families to take an active stance in the lives of their children and to advocate for increasing and improving of these services.
How was this project different for all the other projects you have implemented?
It is a great honor for us to be in Consortium among 6 countries chosen by Special Olympics Europe Eurasia to be part of this project and contribute with our knowledge and experience to the improvement of Developmental Sports Activities, which will help SO coaches in its implementation around the world. Cooperation between so many partners on the project and the knowledge that we are all working towards the achievement of the same goal throughout Europe is a special value that this project carried.
Did you feel/see that the project had an important impact on your activity? How?
Since this program refers to children aged 6 to 12, we have started with the basic skills that give children the opportunity to become aware of themselves and their relationship with the immediate environment. When it comes to activities, we have started with walking and running, balance and jumping, thus helping children learn proper walking, proper running, and how to jump over an obstacle. In addition to these skills, we have practiced receiving and catching the ball, throwing, kicking.
We would like to underscore the preparedness of coaches for working with children with developmental disabilities. The preparedness was achieved by organizing a number of educational seminars for coaches on the subject of Unified Sports. Coaches' essential role in working with children was to adapt the training to their individual needs. Also, that communication between coach, athlete – that is, child – and parent was of key importance, both for the children's success above all, but also for our further success and work. During these three years, following these children, we have witnessed their remarkable progress in various areas – above all, they have improved in terms of their motor skills, coordination, balance and the like. Also, progress was very visible when it comes to cognitive abilities. Their attention span and hand-eye coordination have also improved. Through the developmental sports activities of this inclusive program, children acquire the skills that enable them to engage in specific sports. This helps them develop further as Special Olympics athletes, which will take them to international and world competitions in the future.
We are of the opinion that we already have some future sports champions among us.
Did you feel/see that the project had an important impact on your beneficiaries?
We often hear in conversations with parents that the skills children acquire through participation in Special Olympics training sessions are reflected and carried over into their everyday lives. For instance, children communicate more easily and become better at expressing their needs or emotions, which is exactly what motivates us to keep going and do our best in our work. The training structure is such that the children interact among themselves and get engaged in exercises and activities they do in pairs with others. Consequently, it is inevitable that socialization will be the end result.
Sport is the best way to demonstrate the abilities, the dignity, the pride and joy of people with ID, to enhance their self-confidence, self-reliance, interpersonal, team-member and leaderships skills, to engage people without intellectual disabilities to interact with. It aims to provide children without intellectual disabilities (ID) and the larger community with an opportunity to learn about ID, to understand better and recognize their peers with ID, to demonstrate to the public that people with ID are dignified, valuable and valid members of our communities. Thus, the project has impacted communities to become more inclusive.
This project has connected parents of children with intellectual disabilities. Through this way, the parents network helps them counter the deep sense of isolation and despair that families of children with intellectual disabilities face. Shared experiences and examples of positive parenting break down the stigma and lead to hope, optimism and a sense of empowerment.

“We all know that sports and health represent two side of the same coin. Taking up sports means being healthy. When it comes to Andrej and children in general, sports enhance their team spirit and sense of unity. Both individual and team sports can be of great benefit to him by improving his attention span, which will help him succeed at school.“
Nemanja, Andrej's father“My child has been in this program for a year and a half and I can only say that it is a wonderful project a wonderful program that really yields results. The results were quite tangible even after the first training session, because his focus of attention and coordination improved. We must not neglect the social element and socializing itself -both for them and for us parents. Our entire family has wholeheartedly engaged with the entire process through his involvement, so all of us who are included in it support this project and look forward to every new training.“
Urosh, Sava’s fatherWhat did you like most about this project?
Special Olympics Slovakia is aiming to change thinking of general and professional public to become more inclusive. The project gave us such an exclusive opportunity to be more visible. We can disseminate the inclusion under the umbrella of an inclusive countries like Norway, Lichtenstein, and Island. We got the opportunity to learn from each other.
How was this project different for all the other projects you have implemented?
The extraordinary of this project was reporting. The very detailed reports and summarizing data’s leaded to very specific overview of collecting resources. We believe in SO Slovakia that there are qualified persons validating those all-input data.
Did you feel/see that the project had an important impact on your activity? How?
The impact we feel in increasing numbers of young athletes, family members and FHF events. With this routine we are going to continue in future as the feedback was very positive from involved person and organizations. This commitment predicting the sustainability of FHFs in Slovakia.
Did you feel/see that the project had an important impact on your beneficiaries?
Yes, very much we see and feel impact as we were able to organize 16 Family Health Forums all over Slovakia. These forums helped so much to recognized athletes, family members, volunteer and coaches needs and we were able, thanks to this project, bring them new opportunities in sports and, health through basketball and football. The team spirit was included on fields and in conference’s rooms.
After three years of implementation, we came to the conclusion that the numbers become less important compared to the impact that the sports activities for children or the events organized for volunteers, coaches and parents had for all participants.
In the communities, both children with and without developmental disabilities enjoyed participating in sports competitions and trainings, felt part of the team, laughed, got angry at every referee's whistle.
The coaches were motivated and excited to work with mixed teams, they adapted to the new training requirements for all members, worked patiently and encouraged all the children to feel part of the team, to collaborate on the field and opened the appetite of the little ones to practice any sport in their free time.
The parents or relatives of children with intellectual disabilities received with interest all the advice regarding health, nutrition, exercise in the forums, from the specialists. They enjoyed the new perspective of the project, the inclusion of young people with developmental disabilities in the community, through sports activities. Throughout the three years, they enjoyed their sports evolution, cheered them on from the sidelines, encouraged them in sports tests or the matches they supported, and were proud of their results.
Sport has demonstrated, once again, that it is a great way to make friends and grow a team spirit, in addition to being necessary for children's growth and development.
The European project "Inclusion through sports for children with developmental disabilities" is funded by Iceland, Liechtenstein and Norway through the EEA and Norway Grants Fund for Regional Cooperation.
The project is coordinated and managed by Motivation Romania Foundation in partnership with Special Olympics Romania, SO Iceland, SO Slovakia, SO Lithuania, SO Bosnia and Herzegovina, SO Montenegro, SO Europe Eurasia Foundation and University of Physical Education in Poznan.




At the scientific level
• 9 papers submitted or published
• One special issue delivered in the Politics and Governance journal
• > 2500 NEETs involved in the impact study
• > 500 researchers involved in the project activities (conferences, webinars, workshops) (Oct 23)
• One policy-brief
• 6 national factsheets
• Infographics series
• 2 manuals: good practices and impact assessment
• 6 collaboration agreements with national PES
• 7 regional or national parliamentary hearings
• Multiple opinion articles in national and regional newspapers




• 11,109 target group audience reached through
• 70 dissemination events
• 3 workshops – direct benefit for 4 students, 6 bee breeders, 5 policymakers, 7 researchers
• 5 national policies and laws influenced
• 5 peer-reviewed papers

• 16 researchers/experts supported in tech transfer
• 15 testing sites, 7 concepts, 3 mating control techniques
• Survey for assessment of current status: 88 honey bee breeders (HR, MK, SI)
• Economic analysis – 20 honey bee breeders (HR, MK, SI, ES)





A stakeholder is either an individual, group or organization that's impacted by the outcome of a project.
A questionnaire was prepared to understand transboundary groundwater awareness among project’s stakeholders to identify obstacles when dealing with groundwater issues.
Questionnaire was translated into Polish, Ukrainian, Norwegian, Latvian, Estonian and sent out to developed target group database.

The survey was sent out in 2021 and 2022, and 141 people responded. We used personalized e-mails and social media accounts.
Questions aimed to understand the level of knowledge about groundwater management and transboundary impacts, the interest in the topic, gaps in knowledge and preferred way to gain it etc.
And we understood who our real stakeholders are.

Most responses came from Norway (54), followed by Poland (39), Latvia (24), Estonia, and Ukraine (12).
About half of the people who answered the survey worked for public authorities, like local or national governments. Other respondents included people who worked for education and research organizations or businesses.

The majority know something about groundwater quality and/or quantity, but in general people were little familiar with the term «transboundary groundwater».

All respondents who rate their knowledge about groundwater resources with the highest score are working in relation to groundwater management, exploration or research.
On the contrary, there are 25 respondents who are working in that field too, but rate their knowledge quite low (score 1 to 2).


The respondents also indicated obstacles that are related to data – there are no data or no access to data or they don’t know where to look for data.
In open question respondents also elaborated data-related problems and lack of funding.
The survey results show that there are various obstacles that the respondents face when dealing with groundwater-related work. The most common obstacle was the lack of awareness about groundwater issues from other institutions, followed by the lack of general knowledge about groundwater and a limited number of experts.

• Assessment of the resources of transboundary groundwater reservoirs for PL-UA and LV-EE pilot areas:
• Numerical hydrodynamic model,
• Transboundary groundwater flow assessment.
• Program of transboundary groundwater monitoringPL-UA and LV-EE;
• Harmonization of hydrogeological databases of border areas;
• EU-Waterres MapPortal;
• Assessment of the transboundary impacts on groundwater state in LV-EE and PL-UA pilot areas.






















EU-WATERRES project focusing on shared groundwater sources, known as aquifers, has shown how various countries like Norway, Poland, Ukraine, Latvia and Estonia can work together to tackle water challenges. This initiative stands out because it has found new ways to manage and protect these hidden water supplies crucial for life, agriculture, and ecosystems.
In the heart of the project: sharing knowledge and data
One of the project's key achievements is building a detailed knowledge base about transboundary aquifers. The project has created a map portal called MapPortal by collecting and sharing data. This tool makes it easy for everyone to access information about groundwater. This is important because having the right information helps make better decisions about using and protecting water.

Visit our MapPortal https://eu-waterres.eu/web-app/
The project has brought in new technology to better monitor groundwater. These modern systems can now track water conditions in real-time. This means we can quickly respond to any risks, like pollution or overuse, helping keep our water supplies safe for the future.
Despite facing big challenges, like the COVID-19 pandemic and political issues, the project stayed on track. It showed that working together, even when it's tough, can lead to great results. This teamwork has made the project stronger and more flexible.
Beyond borders: making a lasting impact
The project has done more than just improve how we manage groundwater; it's changing how we think about and act on environmental issues. It's a model for future projects, showing how cooperation can lead to better environmental policies and actions.
Presenting project at the first Groundwayer Summit in Paris

A big reason for the project's success is its effort to involve local communities, governments, and experts. By holding workshops and meetings, it made sure that many different voices were heard. This approach has helped build strong support for protecting our water.
Presenting project is South Africa conference

This initiative is more than just a success story; it's a guide for future efforts to protect our environment. It shows that working together, using new technology, and involving everyone can help us take care of our most important resource: water.
In short, Eu-WATERRES project has not just met its goals but has also inspired new ways to think about and work on water issues. It proves that collaboration and innovation can lead to real solutions for protecting our water supplies.
Thank you from EU-WATERRES team!
We extend our deepest gratitude to the governments of Norway, Iceland, and Liechtenstein for their generous grants, which have been instrumental in the success of our project. Additionally, we are immensely thankful to the Regional Funds Online Magazine for their unwavering support and for spotlighting our efforts.
Europe is facing a pressing issue: integrating NEETs (Not in Education, Employment, or Training) with mental health challenges into the labor market. Stigma, misunderstanding, and insufficient support systems that often fail to address the unique needs and challenges of these young people contribute to high rates of unemployment and social exclusion. The L.I.K.E project acknowledges these issues and seeks to tackle them through a multifaceted approach that engages the entire community.
In order to achieve sustainable employment among NEETs with mental health problems and improve the effectiveness and success of the target group in the labour market, an innovative multidimensional methodology has been developed. The multidimensional program that is being applied in the Youth Houses "Hidden Likes" has become a successfully working system for the integration of NEETs with mental health problems in the labour market and in society. The strength of the multidimensional model and the main reason for its success regarding the specifications of the particular target group is its multidimensional approach which works holistically in several directions. On one side it is directed towards the work with NEETs themselves and their families and close circle of people. On the other side, the model is directed towards the employers’ sector and society in order to reduce the stigma and to raise awareness regarding the target group.
Central to the project's success is its emphasis on understanding the root causes of unemployment and passivity among the target group. Through in-depth studies, L.I.K.E was aiming to identify and address systemic barriers, including social stigma and lack of awareness among employers. By challenging misconceptions and promoting inclusivity, the project paved the way for meaningful participation in the labour market.

Best practices in working with employers include:
• Conducting information and anti-stigma campaigns among employers about the specifics of the target group. Young people with mental health problems face various challenges, including social isolation, stigma, and discrimination, which can negatively impact their well-being and quality of life. Feeling like an integral part of the community can help NEETs feel valued, connected, and supported. It can also promote a sense of belonging, self-esteem, and purpose.
• Creating an appropriate work culture and atmosphere, offering the opportunity to receive feedback and emotional support. Creating an appropriate atmosphere that promotes a positive and supportive environment can have a significant impact on the mental health and well-being of NEETs with mental health problems. Providing them opportunities to receive feedback and emotional support can help NEETs feel valued, supported, and motivated, which can lead to higher levels of motivation and engagement.
• Introducing a system for integrating NEETs with mental health issues on the labor market in the Hidden Likes Youth House that provides a safe environment for young people with mental health problems and their relatives.
Furthermore, L.I.K.E recognizes that sustainable change requires a long-term, multilateral approach. By developing the innovative methodology for motivation and skill-building, the project equips young people with the tools and confidence needed to thrive in the workforce and beyond.
Best practices in working with NEETs which encourage social inclusion and development of life skills:
• Providing greater precision in performing an individual assessment of the needs of every unemployed youth with mental problems as well as identifying appropriate support measures in each individual case. This individualized approach can help address the unique needs and challenges of each individual, promote their well-being, and enhance their chances of successful employment.
• Providing therapeutic services, counseling and support for depression, anxiety, suicide risk, eating disorders, etc. Providing access to mental health services and support can help individuals manage their symptoms, improve their mental health and well-being, and enhance their ability to participate fully in their community and pursue their goals.
• A range of social and practical skills that will integrate them socially, as well as help their inclusion in the labor market. Such activities include:
• Animal therapy;
• Art therapy;
• Gardening
• Sports activities (yoga, gym);
• Seminars promoting healthier lifestyles and personal growth



As a result of all the initiatives and thoughtfully chosen interventions one of the most significant outcomes of the L.I.K.E project has been the improvement in the mental health of NEETs. By offering targeted support, such as counselling, therapy, and skills development activities, the project has provided NEETs with the tools and resources needed to manage their mental health effectively, leading to enhanced overall well-being and resilience.
Moreover, the L.I.K.E project has been instrumental in facilitating the labour market integration of NEETs with mental health issues. By offering career consultations, job placement assistance and ongoing support, the project has empowered participants to secure meaningful employment opportunities suited to their skills and interests. As a result, L.I.K.E has created pathways for NEETs to access job opportunities and develop sustainable careers, thereby reducing their dependence on social welfare systems and fostering economic independence. Remarkably, over 50% of NEETs enrolled in the L.I.K.E. Project and Hidden Likes Youth House activities have achieved successful job placements, marking a significant milestone in their journey towards employment and self-sufficiency. Equally promising is the fact that the remaining participants are diligently pursuing job opportunities and further education with unwavering determination. This collective progress underscores the effectiveness and relevance of the program in empowering NEETs to overcome barriers and transition into meaningful employment.
Furthermore, the project has played a crucial role in promoting autonomy among NEETs with mental health challenges. By fostering a sense of agency and self-efficacy through empowerment programs and peer support networks, participants have gained confidence in their abilities and decision-making skills. As a result, they have become more self-reliant and capable of navigating various aspects of their lives, including education, employment, and social relationships.
In addition to its direct impact on NEETs, the L.I.K.E project has also sparked positive changes in the mindset of employers towards hiring individuals with mental health issues. Through awareness campaigns, training workshops, and employer incentives, the project has challenged stigma and misconceptions surrounding mental health in the workplace. Employers are now more open to accommodating the needs of employees with mental health challenges and providing inclusive work environments that promote mental well-being and productivity.
Our project “Reclaim Our Civil Space!” came to life to address the trends of democratic backsliding and shrinking civic space observed particularly in Central and South-eastern Europe. We have been working for the past 3 years with 10 partners from Poland, the Czech Republic, Slovakia, Hungary, Romania, Bulgaria, Serbia and Norway (as an expert partner) to empower, engage, protect and support our civil societies.
Our activities were planned on the local, regional and European level.
We aimed at broadening the grassroots basis of civil society with training, workshops and mentoring for local organizations. These programmes in each participating country were developed independently, designed upon their previous experiences and tailor-made by our project partners to fit the national context.
Our focus group evaluations showed that the civic groups we reached established new contacts, got to know organizations with similar goals and values, and were able to share their challenges and exchange ideas on resolving them. Some national programmes helped them in identifying suitable sources of funding and strengthened their organizational capacities, improving their sustainability. Other important longterm impacts across the participating countries are the new cooperation and joint projects, and the establishment of new civil society organizations as a result of the local activities of the project. (Most partners were able to help more organisations with more trainings than originally planned thanks to the cost savings made in the first 1.5 years due to the Covid-19 restrictions which forced us to move our capacity building online).
Best practice on the local level: Involving young people by the Bulgarian Environmental Partnership Foundation. Originally planned as a series of consultations for established youth groups/CSOs, the project evolved to respond and meet capacity building needs of young people through a series of activities for school students to help them become aware, active and organized. The subsequent activities were defined by participants at youth meetings (e.g. workshops, debates, fundraising) and the Youth Conference Bulgaria was successfully organized.
We organized 8 cross-border events with participants from at least 3-4 countries from across the region to connect and facilitate co-operation with one another, covering the following topics:
- Vivid Rural Areas (the Czech Republic)
- Human Forum - Human Rights and Democracy (Slovakia)
- Truths that are denied - challenges of post-conflict societies (Serbia)
- Urban Areas as Space for Implementation of Sustainable Policies (Bulgaria)
- Protected Areas and Biodiversity (Romania)
- Local Communities for Heritage: Good Practices in Central Europe (Poland
- New Media and Civil Society Organizations (Romania)
- Youth workshop series on first vote, sustainable tourism and democratic schools (online)
Best practice on the regional level:
1. Partnership Academy - Fundusz Partnerstwa (Poland): was initially an environmental programme for local community leaders, but soon turned into a capacity building academy for 40 civil society organizations and 20 local governments from all over across Poland about natural and cultural revitalisation of the communities, human rights, engagement of women and minorities, advocacy, communication and cross-sector partnerships. Among the main results were the intensive networking (study trips, joint proposals, fundraising); the “Declaration on the Role of Ecotourism in the Protection and Preservation of Natural and Cultural Heritage” signed by several dozen organisations from across the region; sharing the know-how of the Academy methods and approach to the Czech Republic and a joint application to the International Visegrad Fund; the birth of the Partnership Academy brand and growing interest from civil society organizations in other countries.
2. Civic Startups - Civil Society Development Foundation (Romania): was a 9-month capacity building programme for 36 citizens’ groups and grassroots CSOs in early development stages, from all over Romania, in 2 cohorts with webinars, trainings and mentoring (legal and financial assistance, internal governance, fundraising, communication, advocacy and public policies). The programme resulted in an intensive networking of groups active in different fields, and one of its main achievements was when the two cohorts united in a peer-support and resource-sharing community.

We developed together a set of recommendations and advocated for the adoption of a comprehensive European civil society strategy to help create an enabling environment for our civil societies.
We organized 4 international conferences in Brussels, Budapest and Prague on the matter, addressing challenges, such as democratic backsliding, weakening of rule of law and shrinking civic space. A civil society strategy should acknowledge the role of CSOs in upholding European values, review ongoing initiatives and processes that have a relevance to civil society, identify gaps and shortcomings and integrate existing, new and future tools to defend and expand civil space. Hence our recommendations concern 6 major topics: 1) The right to association 2) The right to peaceful assembly 3) The right to operate free from unwarranted state interference 4) The right to free expression 5) The right to cooperation and communication 6) The right to seek and secure resources.
There has been limited room for action, as civil society is largely a Member State competence, but thanks to the efforts of many for a more systematic approach, civil society is becoming more and more part of the agenda on the EU level. The initiative was echoed by EU civic networks, such as the European Civic Forum (of which Ökotárs Foundation became a full member during the project), in reports by Members of the European Parliament - Sergey Lagodinsky, Anna Donáth - and by the European Economic and Social Committee (Jean-Marc Roirant). The call for the strategy became a central demand of the joint civil society campaign towards the European elections. As one important result of all these efforts, it is now certain that the European Cross-Border Association directive is coming, helping civil society organizations to organize without obstacles within the EU!
Our activities on the local, regional and European level are all pointing towards the same goal: to build a democratic and enabling environment for civil society where people take action, get organized and advocate for their interests together freely, without fear or restrictions. Although this project has come to an end, the work goes on and we will do our best to reclaim our civil space!


Closing conference Brussels 2023

The best results stem from collaborative efforts of a great team of experts across nations. When the work of the virologists involved in the Tick-Borne FlaviVirus - TBFVnet project, was affected by the Covid-19 pandemic, and later, when we lost our Russian partners due to the sanctions imposed following the outbreak of the war with the Ukraine, the determination to network, nonetheless ensured the value and integrity of their findings.
TBFVnet established a network of laboratories sharing best practices for detection and surveillance of tick-borne flaviviruses, a class of viruses delivered by ticks which are endemic in eastern and central Europe but moving west. The network wanted to be able to detect the infection, but also to develop antiviral drugs, which were not yet available, and to expand to other regions impacted by the disease, such as Slovenia and the Republic of Moldovia. During the four years of the project, the network published results in scientific journals, and presented these at meetings for both the scientific and lay public. It optimised protocols and key reagents for virus detection, at the molecular and blood serum level, and completed whole virus genome sequencing, which was shared between the laboratories.
The ramifications of education and training in laboratory techniques also through an exchange programme of junior staff between the laboratories in the different countries of the network (Italy, Czech Republic, Slovakia, Norway), has contributed to the establishment of a common strategy on TBFV pathogenesis studies and antiviral drug discovery. The exchange of researchers also contributed to their career development, as doctoral or master students, providing exposure to a different, international environment.
The project has involved tens of researchers, scientists, and students, and a considerable number of the public (200 people live and online attending the public engagement event on the topic; to date explanatory videos on YouTube have reached 1,000 views). The opportunity given to young women in science in the context of the project, to learn and build their own networks for career development, signifies perhaps one of the greatest impacts achieved.
Consolidated and clear media coverage of all these results, particularly at a time when disinformation and the disintegration of the social and democratic fabric is a real threat, undoubtedly constitute some of our best practices.
Most importantly, communications were based on sound scientific knowledge, and prepared by experienced communicators versed in the latest techniques and developments in science dissemination. Thanks to dynamic visuals, regular updates, a broad readership, and the support of the Regional Cooperation Magazine in carrying over some of the best stories, we look forward to the impacts created by the project continuing well into the future.
Suzanne KerbavcicFrom 2021 to 2023, R2G4P spearheaded a comprehensive set of initiatives and approaches promoting good governance across Southeast Europe. R2G4P fostered inclusive dialogue, strengthened regional networks, and championed anti-corruption initiatives. The platform identified and analyzed pressing governance issues, such as the nexus between corruption, state capture, and national security, public procurement integrity, the (mis)management of stateowned enterprises, the need for robust asset declaration checks, and the perils of political pressure and bias in budgetary allocation at central and local level.
In particular, R2G4P:
• utilized innovative diagnostic methodologies and tools, including Opentender.eu, big data analytics, and corruption risk assessments.
• engaged in 27 rounds of Monitoring Anti-Corruption Policy Implementation (MACPI) implementation, empowering public bodies with analyses of the effectiveness of their internal anti-corruption measures, and establishing a culture of continuous policy improvement.
• embarked on a comprehensive capacity-building program.
• extended its reach and impact by forging strategic partnerships with a wide array of stakeholders, including international organizations, government bodies, and civil society groups, including the European Parliament, the European Commission, the European Chief Prosecutor’s Office, Europol, local authorities from the SEE region, anti-corruption and integrity agencies, Norwegian and other EU and SEE embassies, the European Investment Bank, OECD-Sigma, UNCAC, UNODC, the Regional Anti-Corruption Initiative, RACVIAC, the German Agency for International Cooperation (GIZ), and the Interdisciplinary Corruption Research Network (ICRN).
R2G4P's unwavering commitment to combating corruption was further exemplified by submitting joint statements and recommendations to the CoSP10 (2023) and the Rule of Law Reports for 2023 and 2024. The platform's message resonated far and wide, reaching a substantial audience through direct engagement and extensive media coverage. Going forward, R2G4P remains steadfast in its mission to support good governance reforms in SEE. The platform will continue to provide technical support to public bodies, update national anti-corruption strategies, and collaborate with the EPPO and other EU and national bodies to strengthen sanctioning mechanisms through criminal law.
The theory of change of the R2G4P initiative
R2G4P in numbers
Increased capacity and better understanding of corruption risks
• 4 trainings and 3 summer schools
• 3 training manuals
• 322 civil society and public sector representatives trained
• Shared anti-corruption solutions
• 3 SEE Good Governance Reports
• 2 policy briefs

• 3 policy forums, 1 Closing Summit, and 3 webinars with policy-makers
• 33 meetings between CSOs and policy-makers
• 250 civil society organizations engaged
• 776 participants at all events and trainings
• 2,969 people reached and engaged directly
• Better accountability of public institutions
• 27 rounds of MACPI in 9 countries
• Media coverage
• 1 million people reached through conventional and social media


The panelists at the R2G4P Closing Summit, held on 9 November 2023 in Sofia (Hristo Ivanov, MP, Former Bulgarian Minister of Justice; Ute Stiegel, Deputy Head, Legal Affairs and Anti-Corruption Unit, Directorate for International and Horizontal Affairs, Directorate-General Migration and Home Affairs, European Commission; Dr. Ognian Shentov, Chairman, Center for the Study of Democracy; Laura Kovesi, European Chief Prosecutor; Dr. Nikolay Denkov, Prime Minister of the Republic of Bulgaria, Ssssiri Beate Barry, Ambassador of Norway to Romania, Bulgaria and Moldova; Michel Sapin, Former French Minister of Finance,; Lilyana Pavlova, Vice-President, European Investment Bank)

The implementation of the project "Labour market Employment for young Adults with a Disability - LEAD", co-funded by the EEA and Norway Grants Fund for Youth Employment, was a challenge for us with regard to what we wanted to change in the communities which we were addressing to. We introduced in Romania, Lithuania and Portugal a good practice model regarding the Supported Employment, with the help of the team of experts from Status Employment (UK), in order to give a chance to a sustainable integration on the labour market and into society to our beneficiaries.
Now, five and a half years after, I am pleased to say that our efforts, as leading partner, and of the other two beneficiary partners, Valakupiai Rehabilitation Center (Lithuania) and Consultis – Consultoria Empresarial, Unipessoal Lda. (Portugal), paid off.
Our specialists approached in an innovative way the relations among: young adults with disabilities; their parents and tutors; representatives of companies; specialists and providers of Supported Employment services. They worked day after day respecting the methodology and principles of the Supported Employment process, based on the EUSE (European Union of Supported Employment) model.
We opened three Centers of Supported Employment Services, in Romania, Lithuania and Portugal, where young adults with disabilities looking for a job benefited from consultancy and support, at the highest standards in the field. Thus, the young adults enrolled in the project benefited from: vocational profiling, counselling to develop self-confidence; preparing for a job in line with their professional training and interests, developing their working skills, attitudes, behaviours and functional abilities to successfully achieve their employment goals. Moreover, our specialists monitored and supported them during the integration process. We gave time and attention to identify the skills and professional objectives of our beneficiaries in order to value their potential and help them to have an independent life.
Paradoxically, focusing on quality, we exceeded all assumed indicators. Thus, 640 young adults with disabilities aged 15 to 29 benefited by vocational profiling and personalised action plans, and they were involved in Supported Employment activities, within LEAD project. I am pleased to say that 148 of them were employed, 124 young adults with disabilities were enrolled in school programs and/or other qualification training programs, and 120 beneficiaries took part in volunteering activities.
Moreover, our team organised in Romania, Lithuania and Portugal 34 experience exchanges in order to encourage dialogue and to facilitate interactions between the young adults looking for a job and potential employers. At the same time, 889 potential employers benefited from consultancy, as well as training sessions dedicated to Supported Employment specialists. The employers learned how to communicate and how to work with young adults with disabilities, and how to make the most out of the opportunities, especially the fiscal ones, provided by the state to the companies which hire people from this vulnerable segment of society.
The in-work support (based on dialogue and mutual respect) provided by our colleagues was highly appreciated by the employers. Our team worked with the young adults’ new colleagues and the human resources specialists in order to help them communicate constructively with our beneficiaries, and in order to identify the problems which can appear during the integration process, and to solve them. It is a matter of pride for us that most of the entrepreneurs which have worked with us have not stopped at a single young adult with disabilities integrated into their teams. For example, in Romania, we have companies in portfolio that employed 7 young adults, some of them hired in 2018.
Another important direction in our work consisted in providing informational and emotional support to parents and family members of young adults with disabilities in order to help them understand their children’s needs and desires, and to help them motivate the young adults to get and to keep a job. In this respect, our teams organised training sessions dedicated to parents and tutors, and meetings with members of the support group for families of young adults with disabilities.
The integration of young adults with disabilities on the labour market is a complex process. For significant results, two things are needed: a win-win approach of the relationship between the employer and the potential employee and teamwork. Because of these reasons, we established in our countries National Networks of Supported Employment Services Providers. Members have benefited from the opportunity to collaborate, dialogue and act together to solve their problems, and to achieve their goals, including the recognition, by law, of the Supported Employment as a new service for people with disabilities.
We strongly believe that the potential of young adults with disabilities can be harnessed, with immediate benefits for them, for the employer and for society, by applying the Supported Employment model. In this respect, 5 guides will be provided free of charge, after project closure. Thus, companies interested in assuring an inclusive work environment can benefit from two guides, namely “Guide of Good Practice” and “Guidance and Training for Mentors”. In addition, our teams prepared two interesting guides (“Guide in Accessing Supported Employment Services” and “Guide for Supporting Entrepreneurship for Vulnerable Groups”) dedicated to young adults with disabilities, their parents and relatives. Also, the parents and the tutors of young adults with disabilities can benefited from a training package, too.
Young adults with disabilities can be a reservoir of skills and talent, who can bring added value to companies. The LEAD project was based on this premise. During implementation, we have proved hundreds of times that it was a correct premise, so we are still going to support and promote it, just as we are still going to support and promote the Supported Employment model.
We thank all beneficiaries and collaborators for their trust and we assure them that we will not stop here!
Nicolae Dobrescu, Project Manager - LEAD Executive Director of Health Action Overseas Foundation

EURIBOR activities were carried out in:
• Poland
• Bulgaria
• Slovenia
• Spain
• Italy
EURIBOR activities included:
• creating individual support plans for each woman
• psychological support and comprehensive advice on professional issues
• mentoring
• internships and on the job trainings

• regional meetings with local companies and offices supporting women in difficult situations
EURIBOR in numbers:
• Total number of participants recruited 254


• Number of beneficiaries of services provided [NEETs/target group participating in inclusive activities (e.g. training and work-based learning) 195
• Number of women who found job 50
• Number of youth NEETs/target group in the process of starting their own businesses 18
Behind these numbers there are young women whose professional and life situation has been significantly improved thanks to the joint activities of the Partners implementing the EURIBOR project.



• 5 Partners covering 11 CEE countries
• More than 35 documents issued
• More than 45 national and regional events organized
• Stakeholders keenly interested in the project’s results.

Many Thanks to Regional Funds Online Mag for the space to share our thoughts and best moments!
Implemented by:
• Involved professionals who participated in the project implementation: 121
• Youth participated in life Skills program: 251
• Youth participated in onsite digital competence program: 202
• Counseling spent hours: 2175
• Youth got job-related mentoring: 179
• Youth participated in work experience practice: 179





13 partners in the partnership

Over 500 researchers, experts and decision-makers engaged

4 online events, engaging more than 200 participants
9 national-level trainings on the basic concepts and methods of evaluation, engaging more than 170 participants
Over 50 young people engaged


54 country reports prepared


7 comparative, transnational reports prepared
9 national-level closing conferences, engaging more than 240 participants (researchers, decision-makers and practitioners working with youth)
3 transnational stakeholder peer-review forums bringing together researchers and decision-makers to discuss national-level policy recommendations

In the world of honey bees, genetic erosion poses a looming threat, especially as we confront the challenges of a changing climate. Locally adapted genotypes are crucial for navigating these tumultuous times, making honey bee breeding programs indispensable tools for conservation and improvement. However, their success hinges on one critical factor: controlled mating.
One of the BeeConSel goals was designed to test and to provide tailormade solutions for breeding programs in beneficiary countries. Mating
control in honey bees is needed for breeding purposes, where the next generation originates from the most desirable queens. Breeding programs are designed to ensure genetic gain for the wide population, where usually not all stakeholders are participating with their stock. In such a program, it is essential that all participants agree on the minimum criteria and methods used. But, to ensure the sustainability of the breeding program many other aspects must be closely monitored, such as genetic diversity, inbreeding, and genetic gain, but also to be cost-effective.
Our journey began with a deep dive into the world of beekeepers' perceptions and the economics of mating control. As expected, we found that mating control holds great promise, but its implementation is hindered by unproductive legal frameworks and prohibitive costs. We have addressed this problem by modelling what legislation regulating honey bee breeding and mating control should include based on our findings. Five laws and policies have already been influenced, with more likely to follow. It was of high importance to apply the multilateral knowledge exchange and execute unparalleled fieldwork in which we tested several approaches to mating control that can be tailored to local requirements. Later, by verifying their efficiency in the lab, we modelled their performance and selected several as a possible solution for national breeding programs and involved queen breeders. The proposed solutions suggested controlled mating brings a 1.4 - 2.1 gain over the gains in selection without mating. Such a result would make local queen bees more attractive, thus facilitating the preservation of the gene pool and at the same time offering beekeepers a key tool in the selection of desired traits.
But the icing on the cake of all our research and scientific work was definitely how we improved the skills of young beekeepers and queen breeders through workshops and expanded towards equality in a predominantly male profession. The feedback from Magdalena after the Instrumental insemination workshop still warms our hearts:

“I’m overjoyed to have been part of such a project and hopefully, when spring rolls around again next season, I’ll be lucky enough to be invited again. With that, I’ll have one more chance to supplement my knowledge in the area of queen bees and their mating, as well as beekeeping in general, and implement it in realising my business ideas. The thought that I will be among the first to introduce instrumental insemination in the practice of Macedonian beekeeping led me not to regret for a moment that, after 8 hours a day, I sat at the microscope and inseminated the queen. The best feeling was when I did it successfully.”
BeeConSels' legacy is clear: a testament to the power of collaboration, innovation, and a shared commitment to safeguarding the world's buzzing wonders. Through our efforts, BeeConSel has paved the way for a future
where honey bees thrive in their local environment, ensuring that their vital contributions to our ecosystem endure for generations to come.
We have experienced great collaboration between partners from different regions. While occasionally disagreeing in expert opinions, we agreed on this: should another similar call appear, we would apply again. Thematic? Perhaps capitalization and exploitation of obtained results. If novelty would be required, pollinators sound like fun. Something green and something useful, too.
The partner organizations participating in the Competence project has successfully prepared training materials for the development of customer service skills on 5 topics. The effectiveness of the materials was tested at an international level with the involvement of around 250 local government employees.
The “COMPETENCE – Capacity building Of eMployees of municiPalitiEs for beTtEr provisioN of publiC sErvices” project supported by the EEA and Norway Grants Fund for Regional Cooperation was conducted between July 1, 2021 and December 31, 2023.
The goal of the project, which was implemented in the framework of international partnership cooperation, was to improve the quality of public services provided by local governments, to which it contributed by developing two areas. On the one hand, an integrated citizen information platform was introduced, which collects the answers to the most frequently asked questions of clients about municipal services. On the other hand, the project wanted to contribute to the provision of client-friendly public services and increase the efficiency of public administration through the development of communication, intercultural and problem-solving skills of local government staff. For this purpose, the Czech, Croatian, Romanian, Greek and Hungarian partners, with the help of the Norwegian expert partner, prepared training materials specifically aimed at developing the competence of local government employees. Based on the curriculum, an international training series started in September 2023 in the countries providing the partner organizations. The aim of testing the trainings was to measure the quality of the training materials and to solicit feedback from both participants and trainers on the effectiveness of the texts and training structures on the following topics:
1. Communication, negotiation, conflict-resolution and problem solving
2. Civil servants’ attitude towards citizens and integrating citizens’ inputs
3. Digital skills, tools and digital literacy
4. Citizen information platform
5. Applied language (English)
Based on the feedback, the content of the topics was finalized, which can thus be used effectively to achieve the defined training goals. The texts were proofread by Business Coach Ltd.
1. Communication, negotiation, conflict-resolution and problem solving and 2. Civil servants’ attitude towards citizens and integrating citizens’ inputs
The trainings that can be conducted using the materials developed in the topics are suitable for the participants to learn the basics of professional, effective, and assertive communication. As a result, they will be able to analyse conflicts, deal with problematic situations consciously, while being able to put themselves in the clients' shoes to understand their point of view. Furthermore, they can use appropriate techniques to manage the stress resulting from challenging situations that arise during their work and everyday life.
The continuous development of digital technologies results in new and flexible ways of working. For municipal employees to make the most of the opportunities and challenges of the online environment, it is essential that they become digitally literate. The trainings held using the materials of this topic are aimed at increasing the digital skills of the employees.
Materials here
Local governments can benefit from the introduction of a modern online information platform that helps clients find out about municipal services. In the first step, it is worth developing to support social services. When preparing the texts for the platform, the local government employees who work in the field and are therefore in daily contact with clients can formulate the answers to the most frequently asked questions in a way that is comprehensible to the public, while maintaining credibility. The communication manual of the platform helps with the design of the online interface.
Materials here
This material introduces an efficient course structure for applied English language aimed mainly but not only to encourage public servants to enhance their language skills, for which it primarily offers grammar aids and useful exercises.
To facilitate their use, the topics have been provided with document summaries, which describe the purpose of the given training material, the primary and secondary target audience of the text, and the suggested way of using the content.
The training materials can be freely downloaded from the given links. We can recommend their use to everyone!
This training material was compiled in partnership within the framework of the COMPETENCE project by

Materials here
The partner organizations of the Competence project introduce modern integrated information platforms for their clients.
The “COMPETENCE – Capacity building Of eMployees of municiPalitiEs for beTtEr provisioN of publiC sErvices” project supported by the EEA and Norway Grants Fund for Regional Cooperation was conducted between July 1, 2021 and December 31, 2023. The goal of the international project was to improve the quality of public services provided by local governments, to which it contributed by developing two areas. On the one hand, the program aimed to develop the communication, intercultural and problem-solving skills of the employees, for which the local government specialists developed educational materials that can be used for further training. You can read more about the project activity here, the training materials are shared in downloadable form at the end of the article: “Improving customer service skills”

On the other hand, the modern citizen information platforms that are introduced as a result of the project help raise the standard of public services, which collect answers to the most frequently asked questions of clients about municipal services. We are convinced that informing clients cannot consist only of the publication of specific services and their brief summaries on the official website of the place providing the service. In doing so, the institution fulfils its statutory obligation to provide information, while the detailed questions of interest to clients are often not included on the webpage. Furthermore, the information shared on the official websites may contain jargon, the knowledge of which is not expected from the clients. Meanwhile, many people do not know what municipal services they could use in their given life situation. Searching for information is particularly difficult and time-consuming if you have to gather the necessary data about services and terms of use on several channels. For example, it is in vain to find out from the website that the local social institution has the possibility to provide home assistance, if information about the necessary conditions of the service and the documents to be submitted can only be obtained by e-mail or by phone during customer service hours. Complete information can save working time on the service provider's side, and sufficient information can save free time on the client's side.
Therefore, local governments can highly benefit from the introduction of a modern online information platform that helps clients find out about municipal services. In the first step, it is worth developing to support social services, but definitely to the human services (e.g. education, healthcare, social services, child welfare, etc.). Local government employees who work every day on the provision of human services, and thus also interact with clients daily, learn communication methods suitable for clients during development.
When preparing the texts to be posted on the platform, they are able to formulate the answers to the most frequently asked questions by clients in a way that can be well understood while maintaining credibility.
The platform to be introduced by the Újbuda Municipality is available to clients at https://info.ujbuda.hu. The URL of the platform can be adapted to the existing or newly acquired domain name of any local municipality. Interested local governments can find out about the conditions for using the platform through the following contacts of the project's Norwegian expert partner organization (Åpenhet AS):
- Thibault Rabussier, thibault.rabussier@apenhet.com
- Yasser Lahbibi, yasser.lahbibi@apenhet.com
The communication manual of the platform, which can be downloaded from the link here, helps with the design of the online interface.
Materials
Important national and regional disparities remain in the school to work transition domain, especially among the most vulnerable groups. In 2022, the share of NEETs ranged between 4.2% in The Netherlands and 19.8% in Romania and were higher in rural areas (12.6%), compared to cities (10.9%) or towns and suburbs (12.2%). This trend was evident in 11 out of 27 countries, particularly in Eastern and Southern ones, with differences sometimes reaching 10 to 15 percentual points (e.g. Lithuania) according to the Eurostat. The same pattern has been observed for other indicators, such as youth unemployment or tertiary education attainment.
The policy response to these regional asymmetries is inconsistent, failing to scale-up public services’ impacts. According to recent reports, the Youth Guarantee coverage is uneven to say the least, ranging from 2.6% in Hungary to 65.9% in Lithuania, with the EU27 average coverage reaching 40.3%. In the meantime, new policy instruments, such as the Recovery and Resilience Framework national plans do not compensate for the subnational disparities in school to work transition, particularly in Southern countries where these disparities remain greater.
Public services, particularly Public Employment Services (PES) can play an important role in mitigating limitations in policies implementation and improving the odds of NEETs social and labour market inclusion. However, as digitalization of public services spreads, school to work transition is also growingly happening outside the institutional support framework, particularly in the case of most vulnerable young people. This is more often the case in rural and peripheral areas. This trend is due to PES service delivery being often mismatched from vulnerable young people’s, skills, services centralization or dismantlement and increasing relevance of informal sources of support, including family, friends, personal social networks or social media for job search among vulnerable youth.
The Track-IN project aimed to understand how exactly PES service delivery was meeting rural NEETs needs, taking into consideration an increase on digitalized services deployment, in the aftermath of COVID-19. Specifically, our vision was to deliver an evaluation model of the effectiveness of Public Employment Services (PES) tracking support types - digital, human-mediated or mixed - in improving employability among rural NEETs aged 25-29. We also intended to do so on Baltic, South and South-eastern States with disparate rural NEETs’ proportions and different degrees of PES digitalization.
The results of the Track-IN project can be found in multiple scientific outputs, including 9 scientific papers, one special issue on the Politics and Governance journal as well as on other deliverables targeting service providers and decision-makers (e.g., one policy-brief, two manuals and series of national factsheets). Below, we share the most important conclusions of our effort to better understand the role of PES for effectively supporting rural NEETs.
Our main research results can be located at three different levels. At the policies level, we found that here is little consensus on the definitive age group at which NEETs could be targeted and on the actual need to target them as such. Furthermore, welfare regimes considerably shape on-theground policies for NEETs, with important gaps found in Southern and Eastern countries where institutional support and services capacity is more limited. Moreover, policies continue to show gaps in terms of adjusting programs to different territories, thus not addressing increasing gaps between more and less affluent areas. At the services level we were particularly (although not exclusively) interested on the effects of digitalization.
Despite several practical advantages (e.g., releasing staff from time‐consuming administrative tasks), PES digitalisation will only be beneficial for vulnerable young people such as rural NEETs if three interrelated challenges are considered: nurturing trust in institutions and digital tools, supporting digital transformation of PES institutional organization, and adopting a co‐design lens for PES digitalisation. At the individual level, two main conclusions were very relevant for the project’s team. First, among non-urban NEETs, life satisfaction is positively associated with PES onthe-ground availability, while a positive self-efficacy is connected with higher levels of social support provided by friends and family. Thus, a combination of accessible services with informal support are key to promote well-being which, in turn, is usually associated with better labour market integration outcomes. Secondly, stronger emotional, interpersonal, and practical support received from PES is associated with stronger odds of rural youths transitioning from the NEET status to an active work status. As a conclusion, the main lesson learned here is that the quality of interpersonal support matters to activate NEETs, meaning that bureaucratic staff approaches as well as digitalization are not enough to effectively support vulnerable younger generations in the countryside. Our findings contradict, therefore, the dominant techno-optimism in public services provision, showing that there are nuances which prevent digitalization from being effective. Adapting the benefits to different groups is key to make sure inequalities in social services provision does not grow due to digitalization.

Public services, particularly Public Employment Services (PES) can play an important role in mitigating limitations in policies implementation and improving the odds of NEETs social and labour market inclusion.
On December 12, 2023, the Pere Closa Private Foundation held the final conference named ¨Transition from school to the labour market¨, in Badalona Sud. We invited social and labour agents, NGOs, and labour office services to reflect on the territorial difficulties and opportunities to improve the school-work transition period and increase the employment opportunities of young people at risk or social exclusion. The conference was organized in the framework of the final dissemination event, synchronized with the rest of the partners from the European project SEPAL PRO.

Through the positive experiences of the Pere Closa Private Foundation, in collaboration with more than 20 local stakeholders, and the work shared with 4 European collaborators, the objective of this day was to connect
current resources, consolidate a network of work that enables the nurturing of the territory and seek social promotion. The debate of the conference was oriented on trying to give a response to the following questions: How can we implement European policies at a local (micro) level? What measures can we take to prevent young people from disengaging from the education system and encourage them to continue? What opportunities already exist in the territories to accompany young people in the school-work transition period and prevent them from becoming invisible? What can the Administration and organizations contribute to deal with the problem of youth unemployment? How do we motivate our youngsters? How are references built? Is absenteeism a matter of expectations?

The participants of the day drew together the following conclusions and proposals.
• The socio-political context of Badalona is very complex, which makes it difficult to apply social policies and actions, which represents an additional challenge.
• The importance of having spaces for analysis and reflection that involve different economic and social areas and that allow the emphasis on the construction of joint, situated, and concrete action models, which is why this conference is highly valued.
• It is necessary for the Department of Education and Work to establish joint work lines that allow the development of micro-skills training actions aimed at improving the acquisition of labour skills and increasing opportunities for job insertion.
• It is necessary to develop models of accompaniment and support for young people that include preventive actions aimed at restorative practices for emotional well-being, social skills, and emotional management. Offering spaces of proximity, trust, and security that allow for healthy, solid bonds and co-responsibility to be established. In addition, it highlights the need to carry out prevention actions before they leave the education system, that is to say, at least between the ages of 14-16 to increase the chances of prospecting.
• To improve the school-work transition, resources, territorial services, the Administration must be connected... in other words, it is necessary to carry out a real network task and involve all the socio-educational systems and agents in which young people and adolescents develop. Carry out joint, coordinated, and non-sectoral actions that advocate transversality, co-responsibility and collaboration.
• The great importance of changing the term studying to learning is highlighted, to be able to see the educational field in a different way together with the students. Also, the importance of the family and its involvement with the students is highlighted, to improve the participation of minors in school.
On Thursday, the 14th, and Friday, the 15th, two days of result analysis and international dialogue took place in Palermo, at the exclusive venue of the Giardini del Massimo.

Common goals, shared experiences, and a crossroads of diverse cultures formed the three key elements that completed the final puzzle of the StayOn project. Reaching its natural conclusion, the project culminated in a two-day event within the exclusive setting of the Giardini del Massimo, offering the liberty-style ambiance of the painting hall and the comfortable, modern spaces of the vaulted hall.
Thursday, the 14th, marked the beginning of the proceedings with the welcoming of all European partners engaging in various activities for discussion and exchange. Roundtable discussions on various projectrelated topics took place, covering experiences of working with young migrants and refugees, integrating local culture as a tool to connect
stakeholders with young NEETs, analyzing coaching tools, and creating communication channels as expressions of young people's needs.

On Friday, the 15th, the final conference took place with the presence of project managers from partner countries, the Department of Agriculture of the Sicilian Region, local institutions, training course organizing companies, and the EEA Grants investment fund that supported the entire project. The day's presentations involved the active participation of all organizations from the European countries involved: "Rezos Brands S.A." for Greece; "Meath Partnership" for Ireland; "Creasaçor" for Portugal; "Atis" for Italy; "The Polish Farm Advisory" for Poland; "BB Consulting" for Slovenia, and finally, "ECSF Gmbh" for Germany. This melting pot of cultures punctuated the event's moments with panels and talks on various topics, such as investing in the potential of youth organizations through community-based approaches or the role of culture and its impact on managing community projects for the new generations.

In conclusion, space was given to StayOn's final Manifesto, an institutional document signed by all partners, laying the foundation for a European alliance with the following objectives: harnessing the human potential of youth in rural communities by providing them with platforms and communication tools; promoting a culture of sharing and mutual growth among partners; laying the groundwork for a long-term impact on rural sustainability; involving a multitude of stakeholders to broaden the influence and scope of the European alliance.
StayOn ProjectBecause most European project managers are self-taught, the chances are that you learned to master the art of taking the reins through years of hands-on experience and, let’s admit it, many virtual meetings with fake nods and smiles, jotting down notes while pretending to understand.
So, the first idea for a book began with the intention of offering a survival guide to novice European project managers as well as aiding my own understanding of the challenges involved in managing transnational partnership projects.
To me—smelly clothes aside (or not, depends on your project partners)— these consortia often resemble the motley crews found on 17th- and 18thcentury sailing ships, composed of individuals from various nationalities, each driven by distinct motivations, yet collectively pursuing a common objective. Nevertheless, anyone who has watched a maritime movie understands that the passage of time can be unforgiving to any crew. This book challenges the status quo by addressing the often-overlooked aspect of collaboration. In a landscape where project partners are encouraged to work together but left to navigate the complexities alone, this book takes a systematic approach by breaking down different practices and offering tangible guidance.
• It shows the NUDGES needed to move away from worst practices embedded in the stale, corrosive presumption of “this is just another project.”
• It explains how to best deal with PUSHES or overt cases of tension, which many times represent action opportunities to turn things around.
• It illustrates how SHOVES or moments of forced renegotiation might still be the chance to get your project on the right track.
 Parola, ECSF GmbH
Parola, ECSF GmbH

What is the Global Entrepreneurship Network (GEN)? What are its objectives, and what programs does it promote?
"GEN Global stands as a thriving community dedicated to supporting founders worldwide. Our core mission is to build a robust scaffolding for startup ecosystems, offering access to essential resources like people, capital, and innovative programs. Key initiatives include the Entrepreneurship World Cup (EWC), Global Entrepreneurship Week (GEW), and Startup Huddle. By partnering with policymakers, investors, and community builders, we aim to tackle entrepreneurship barriers head-on."
As Director of GEN Startup Programs, do you see any evolution in entrepreneurial ecosystems around the world? What can we expect for the future? And in the case of Spain?
The entrepreneurial landscape is indeed evolving. A key indicator is the rise of full-time entrepreneurs with sufficient resources to develop their products. Global challenges like the pandemic and climate change have had mixed impacts – posing obstacles but also fueling innovation. In the future, we can expect technological advancements, particularly in AI, to
reshape industries. Spain, mirroring global trends, shows promising growth despite these challenges."
The Global Entrepreneurship Congress (GEC) was held in Melbourne a few months ago. What is your assessment of it?
"The GEC in Melbourne was a triumph in advancing global and local startup ecosystems. Its diversity and richness in content have consistently impressed since my first attendance in 2017. The event significantly strengthened our ties with the Australian startup community, fostering connections with investors and policymakers."
One of your functions is to dynamize and coordinate Startup Huddle. How does Startup Huddle help entrepreneurs meet their challenges?
"Startup Huddle is a catalyst for startup community growth. It facilitates vital connections for founders, aiding in talent acquisition, investment opportunities, and overcoming cultural barriers. This grassroots program, led by passionate founders and supporters, is pivotal in building a supportive ecosystem for startups."
What assessment does GEN make of the implementation of its programs in Spain in collaboration with Autoocupació and other institutions?
"In Spain, our collaboration with Autoocupació has been remarkable. Their active leadership in Startup Huddle has not only benefitted local communities but has also demonstrated effective scaling at a national level. This collaboration is a testament to the power of coordinated community efforts."
YES! Project

In a ground-breaking initiative, the project CODE Europe has spearheaded a movement to empower citizens in co-creating policies alongside decision-makers through the innovative mechanism of Crowdsourcing. This participatory democracy approach harnesses the capabilities of technology to tap into the collective wisdom of the masses. The aim is to provide citizens with a platform to learn from one another, collaborate, and actively engage in the decision-making process.
The CODE Europe project has engaged citizens in six European countries, focusing on the critical issue of air quality. The choice of this topic is deliberate, considering its transnational implications and the alarming statistics linking it to over 400,000 premature deaths annually. Additionally, through its sister project DiGiDem four more European countries were engaged in the crowdsourcing, which culminated in proposals to improve the Revision of the Ambient Air Quality Directives currently under review by the EU.
From January to March 2022, Phase One, titled "Problem Mapping," witnessed the active participation of 45,888 European citizens who identified specific air quality challenges in their daily lives. This phase aimed to comprehensively map the issues faced by citizens concerning air
quality. Following this, from April to July 2022, Phase Two, known as "Problem Solving," engaged 44,719 European citizens who proposed solutions to the identified air quality problems, emphasizing collective intelligence for effective solutions. Moving on to Phase Three, conducted from August to October 2022, 6,487 European citizens participated in "Ideas Selection," registering and digitally identifying themselves to evaluate and select the most promising solutions from Phase Two. The focus was on highlighting popular ideas and priorities for presentation to policymakers at the EU, national, and local levels. Lastly, in Phase Four, spanning from October 2022 to January 15, 2023, 1,130 European citizens actively collaborated with experts and digitally identified themselves to refine policy proposals on air quality based on insights gathered in the previous phases.
The culmination of these efforts has led to the development and presentation of ten proposals by CODE Europe to policymakers, aimed at improving air quality in Europe:
• More Green Space in Cities
• Increased Cycling and Walking Infrastructure and its Quality
• Taxing Big Polluters
• Support for Renewable Energy Infrastructure
• Strengthening Public Transport Networks in Non-Urban Areas
• Establishing Rules for Zero Emission Industries
• Enforcing Improved Building Insulation
• Electrifying Bus Fleets
• Establishing a 30 km/h Speed Limit in Cities
• Supporting Workshops and School Programs to Increase Awareness about Air Pollution and Environmental Protection.
To spread the experience of using crowdsourcing to influence public policy decision-making, CODE Europe has created the Innovative Online Course "Crowdsourcing for Civil Society Organisations"
The course is designed to empower individuals with the knowledge and skills necessary to harness the full potential of crowdsourcing for impactful citizen involvement. This carefully curated course addresses diverse facets of crowdsourcing, providing a comprehensive understanding of its applications in citizen organizations, national contexts, EU-level initiatives, technological setups, and citizen engagement campaigns. Drawing on the valuable experience gained during the implementation of the Co-Deciding Europe: Civic Tech for Good Governance and Active Citizenship (CODE Europe) project in 2021-2022, this course offers invaluable insights for those seeking to make a difference.
Module 1: The Basics of Crowdsourcing
Embark on a journey through the fundamentals of crowdsourcing, exploring its definition, historical context, and underlying principles that make it a potent tool for citizen engagement. Compare crowdsourcing to other EUlevel tools for citizen participation and delve into national examples from Iceland and Finland, showcasing the effective use of crowdsourcing in codecision making with citizens.
The course is now open for enrolment, and it's absolutely free! Registration is required to embark on this enriching educational experience. Don't miss out on this opportunity to enhance your understanding of crowdsourcing and drive positive change in your community. Enrol now and take the first step towards becoming a catalyst for citizen-driven decision-making!
By leveraging the collective intelligence of European citizens, CODE Europe is paving the way for a more inclusive and impactful approach to shaping policies that address pressing issues like air quality. The journey continues as these proposals move from crowdsourced ideas to potential
legislative action, bridging the gap between citizens and policymakers for a brighter, cleaner future.
CODE Europe was implemented by a consortium led by CSS - Centre for Social Sciences, Hungary and included the European Citizen Action Service (ECAS), ProInfo Bulgaria, the European Environmental Bureau (EEB), Citizens Foundation Iceland, DAEM Greece, OneSource Portugal, ScIFY Greece, Inepa Slovenia, Providus Latvia, EGA Estonia and Manabalss Latvia.
Looking at the situation and background of NEETs over 25 and addressing the various factors and vulnerabilities they face; it became clear that NEETs over 25 in particular often have lower incomes and a higher risk of poverty than their counterparts. Many faces financial problems, including significant debt, especially in the 25-29 age group. In addition, NEET rates tend to be significantly higher in rural areas where access to education, job opportunities, and infrastructure is limited. The prevalence of school dropouts in rural areas contributes to these high NEET rates. Health problems, both mental and physical, are common reasons for NEET status in this age group. NEETs are more likely to have mental health problems and often face long-term health problems that prolong their NEET status. Furthermore, gender differences are evident, with women more likely to be NEETs than men. Caregiving responsibilities, gender discrimination in education and employment, and adherence to traditional gender roles contribute to these differences.
Building upon this, it is important to understand that the group of NEETs over 25 is very heterogeneous. There can be different reasons why a person is a NEET and these reasons, in turn, can shed light on why NEETs remain in this status for a longer period of time. Some NEETs have (chronic) health problems, others are young mothers, and still others have low formal education and/or live in areas/countries with a difficult labour market situation. The mentioned reasons for NEET status should not be considered in isolation, i.e. there are often multiple reasons why 25–29year-old young people become NEETs or remain in this status temporarily or long-term: due to their heterogeneity, 25+ NEETs have very different needs and face different challenges.
Moreover, there are country-specific and systemic factors that influence the risk of becoming and remaining NEET. For example, lower NEET rates at age 25 and older may generally be associated with higher levels of GDP. Income inequality tends to correlate with higher NEET rates, as is the case in Romania, Bulgaria, Greece, and Spain, all countries with high NEET rates. Particularly between 2018 and 2020, these countries specifically have experienced an increase in income inequality. In general, countries with higher income inequality also have a higher proportion of people at risk of poverty or social exclusion. Spain and Greece generally have one of the highest unemployment rates. In Spain in particular, the labour market has deteriorated rapidly due to crises such as the financial crisis and the COVID-19 pandemic – which has also led to an increase in the number of NEETs. The impact of these crises has varied from country to country; countries with low 25+ NEET rates, such as Malta, were only moderately and temporarily affected by the pandemic. However, as these crises created uncertainty in most countries, especially in the labour market, it is particularly important to use the experience gained in recent years to reduce NEET rates among those over 25 in general, but also to take measures to prevent the number from rising again in the event of a future crisis.
Therefore, the NEET status for young people over 25 is shaped by a complex interplay of factors, encompassing socio-economic conditions, urbanization, health, ethnicity, gender, and discrimination. A comprehensive understanding of these challenges is essential for the development of effective policies and interventions aimed at supporting and reintegrating NEETs into education and employment.

Centre for Social Innovation
https://lostmillennials.eu/
From the Fund Operators
Mateusz Wiśniewski
Francesca Bombarda
Sara Barbi
Małgorzata Nowak
Cristiana Gaita
External Contributors
Thomas Mc Grath
Biliana Sirakova
Social Cooperative of Limited Liability
Koi.S.P.E. “Diadromes”
Anna Saroukou
Rosa Messuti
Aimilia Markaki
Anna Saroukou
Jose Fernandez
Alina Gafița (Adomnicăi)
Tanja Dimitrijević
Inga Retike
Suzanne Kerbavcic
Nicolae Dobrescu
Francisco Simões
Elena Marta
Mariano Soler
Giulia Parola
FRA - European Union Agency for Fundamental Rights
DIRECTOR
Gian Luca Bombarda
Stella Wolter
Alina Adomnicăi
Monika Peter Tzvetkova
Kyriaki Kyprianou
Laura Pacareu Flotats
Kremena Yordanova
Serbanescu Maria Cristina
Francisco Simoes
Eszter Szonyi
Teodora Ivanova
Anastasia Vlachou
Savvas Pavlidis
Marieta Ivanova
Bálint Farkas
Špela Kodre
Fabio De Pascale
Aleksandra Ziębka
Monica Tautul
Cover image: free library
The contents of the Magazine are the sole responsibility of the authors and can in no way be taken to reflect the views of the Donors.
Born with the intention of sharing the results and updates of the projects participating to the Funds to showcase the main achievements of implemented activities.
Follow us:
www.youthemploymentmag.net
www.regionalcoopmag.net

Contact us: themag@regionalfundsmag.net
Official number: 3380/2019

FUND OPERATED BY:
